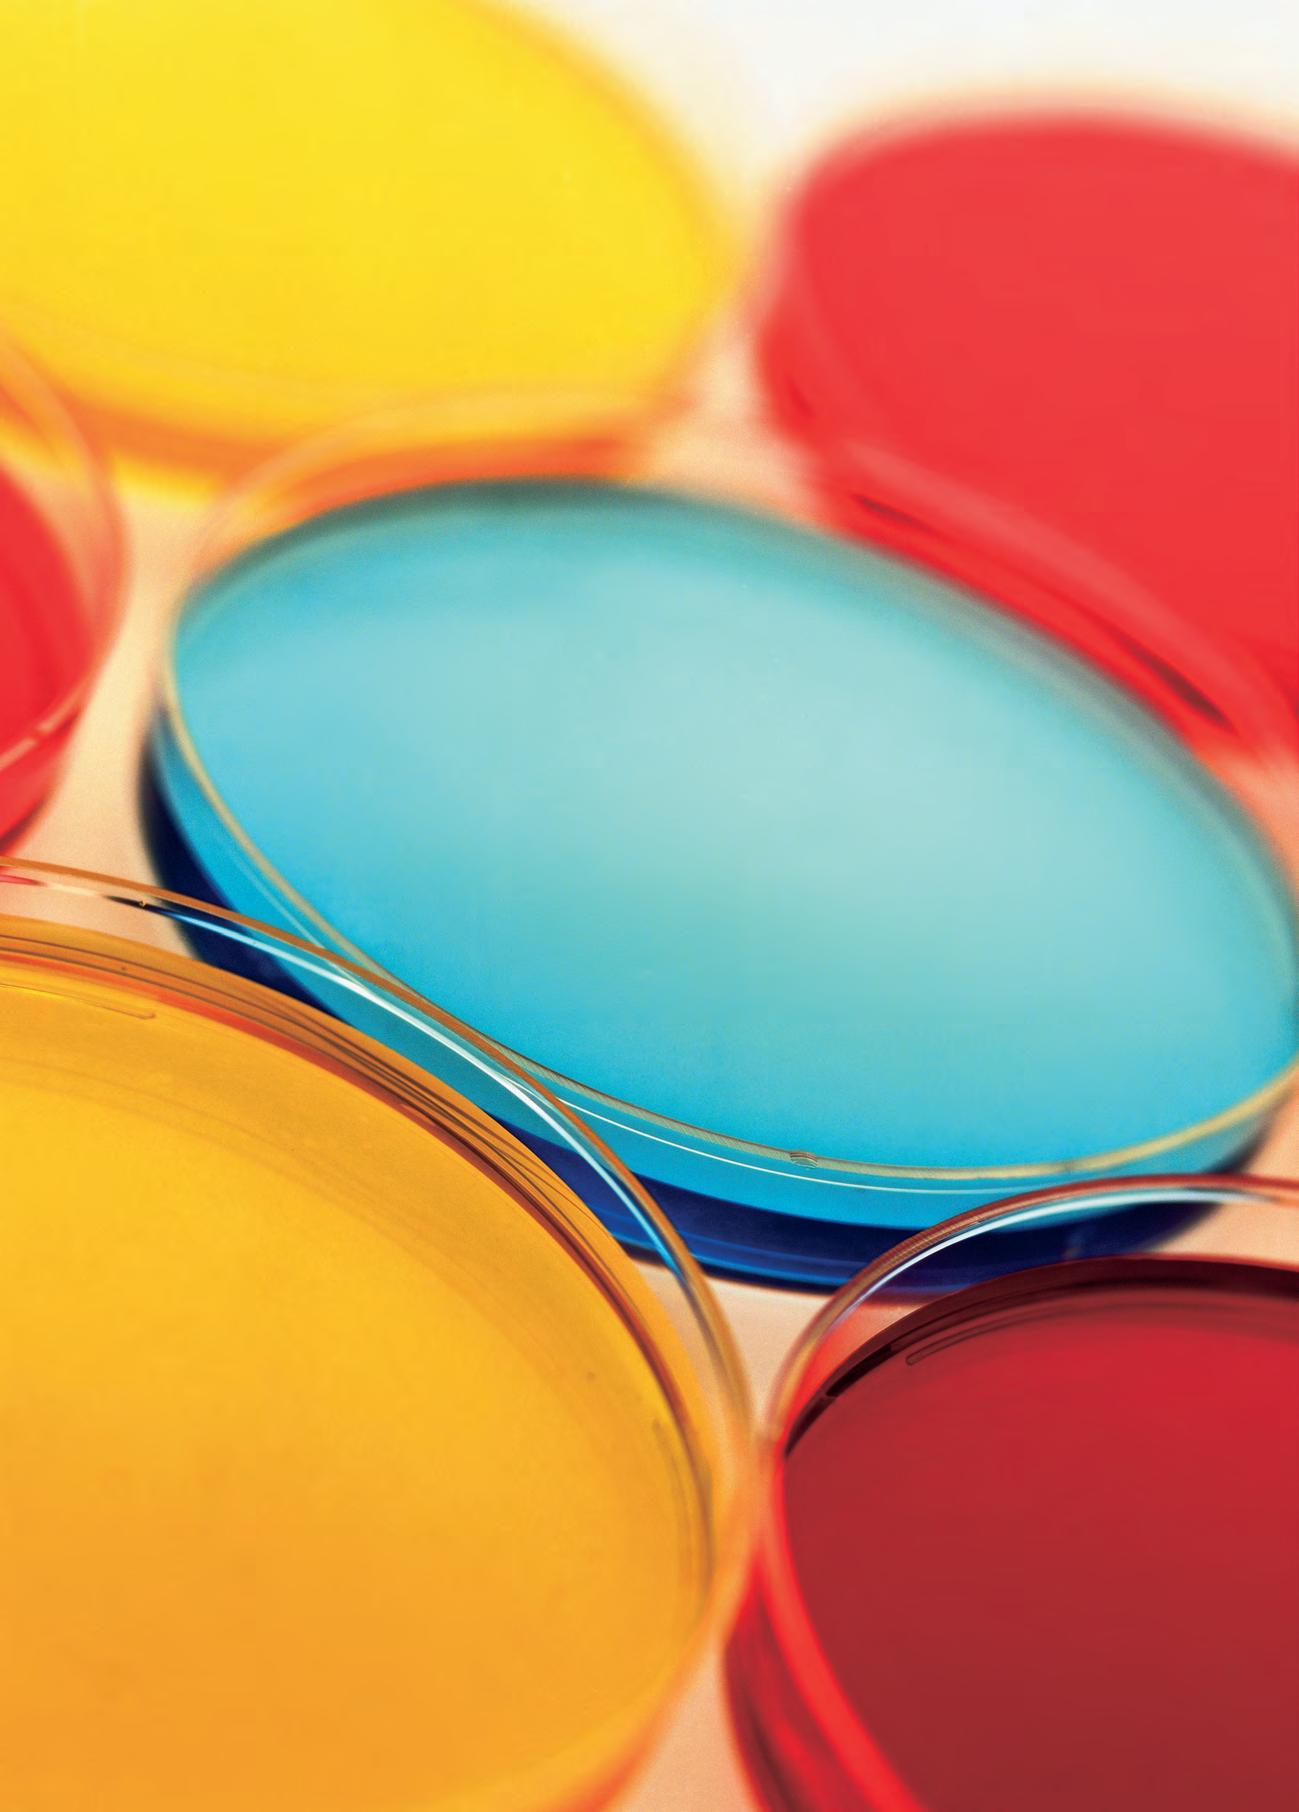

Q enlace
de los químicos de Madrid
REVISTA DEL COLEGIO Y ASOCIACIÓN DE QUÍMICOS DE MADRIDN.º 48 | JUNIO 2024

![]()
REVISTA DEL COLEGIO Y ASOCIACIÓN DE QUÍMICOS DE MADRIDN.º 48 | JUNIO 2024

Entrevista con Juana Bellanato Fontecha, pionera de la química española: “Creo que he hecho bastante bien a la gente en el sentido científico”
El aceite de oliva virgen extra y los ‘guardianes de la salud’

La búsqueda de la excelencia es el camino por el que llegar a algo extremadamente bueno o sobresaliente. Al final de este camino, siempre se llega al éxito porque no hay excelencia sin éxito, aunque sí que podría haber un éxito sin excelencia.
Desde el Colegio y la Asociación de Químicos e Ingenieros Químicos de Madrid procuramos una ordenación y defensa de la profesión en nuestro territorio, una formación continuada de nuestros colegiados/asociados bajo el amparo de nuestro código deontológico, y que nuestros profesionales ejerzan la profesión de manera excelente.
Este año tenemos tres proyectos excelentes que queremos compartir con vosotros:
Uno. Hemos celebrado el primer concurso de proyectos de excelencia química para alumnos de bachillerato. En esta primera convocatoria se invitó a participar a los 17 IES de la Comunidad de Madrid con programa de excelencia en bachillerato con un proyecto científico. El primer premio fue para los alumnos Alejandro Font Boufard y Yago Martínez Balvin, por el proyecto “Nueva generación de antibióticos basados en compuestos organometálicos: Una respuesta a la aparición de bacterias resistentes”, dirigido por la profesora Marta Moran Bayón, del IES El Burgo-Ignacio Echeverría de Las Rozas de Madrid. Un ejemplo de que la excelencia es el camino hacia el éxito y por ello, de el año que viene, queremos repetir el concurso, pero esta vez invitaremos a todos los centros educativos de la Comunidad de Madrid, tanto públicos como privados y concertados. Y queremos replicar este concurso en Castilla-La Mancha, Ceuta, Melilla y aquellas provincias de la Junta de Castilla y León que pertenecen a nuestro centro territorial.
Dos. En la búsqueda de la excelencia, desde la Sección Técnica de Educación
se ha elaborado un libro de experimentos para talleres científicos en colegios e institutos y también para hacer en casa. Para garantizar la seguridad hemos lanzado un curso de formación científica para monitores de tiempo libre de manera que sepan evaluar los riesgos y peligros que conlleva cada experimento y que no cause ningún problema ni al profesorado ni al alumnado.
Tres. Por último, pero no menos importante: somos el primer colegio profesional
CC Tras el primer concurso de proyectos de excelencia química para alumnos de bachillerato, el año próximo se extenderá a todos los centros de Madrid DD
que ha solicitado tener una patrona y un patrón (San Alberto Magno). La elegida como patrona es la Beata Guadalupe Ortiz de Landázuri y Fernández de Heredia. Muchos de vosotros, que no pudisteis estar en la presentación de esta, me habéis preguntado por qué la hemos elegido, y la respuesta es muy fácil: es mujer (ya teníamos patrón), es química, es de Madrid y es beata. Guadalupe fue un ejemplo de amor a la química y también fue un ejemplo de emprendedora, tanto en obra social como en ámbito profesional, donde lideró la dirección de diferentes residencias de Estudiantes en Madrid, Bilbao, México y la dirección del Opus Dei en Roma, siempre acompañada de sus libros de química. De hecho, cuando regresó a Madrid, por problemas de salud, 18 años después de haber terminado la
carrera, inició su tesis doctoral, que compaginó con clases de física y química en el IES Ramiro de Maeztu y el IES Santa Engracia. Según sus compañeros profesores y alumnos, era una gran docente, que despertó mucha vocación química, al tiempo que divulgaba las bondades de la química. Creo que sus cualidades como pionera, emprendedora, divulgadora y, sobre todo, por su amor a la química y por ser un ejemplo de santidad desde la normalidad, como dijo el papa Francisco durante su beatificación, justifican la elección.
Pero esto es solo el principio del camino de la excelencia y no terminaremos hasta alcanzar el éxito y por ello ya estamos trabajando en muchos más proyectos igual de ilusionantes que estos, como el congreso que celebraremos en noviembre, para celebrar San Alberto, sobre la descarbonización de la industria. Un tema en el que la química y sus profesionales, químicos e ingenieros químicos, tenemos mucho que decir. Allí se explicarán los programas de éxito, la innovación del sector y se realizará una visita a las instalaciones del Polo Químico de Puertollano, donde ya están llevando a cabo este tipo de políticas. También habrá un ciclo de conferencias; entre ellas una sobre el papel de la química en el sector vinícola y otra sobre el certificado químico sanitario, tan demandado por los profesionales del sector. En definitiva, desde el Colegio la Asociación de Químicos e ingenieros Químicos de Madrid seguimos trabajando en proyectos que mejoren a nuestros profesionales, les faciliten formación y divulguen las bondades de la química, ya que, gracias a ella ha mejorado y avanzado tanto nuestra sociedad, y que podamos seguir diciendo que la química mola.
Iñigo Pérez-Baroja Verde Decano-presidente del Colegio y la Asociación de Químicos de Madrid Q
La química del ángstrom y el attosegundo
Juana Bellanato Fontecha, química experta en espectroscopía: “Creo que he hecho bastante bien a la gente en el sentido científico”
El AOVE y los guardianes de la salud
Hacia la excelencia desde el bachillerato
La industria química, un sector sostenible, competitivo y resiliente
Presente y futuro de las baterías de litio y su reciclado
La cernada: un material reciclado para aparejar lienzos en Madrid en el siglo XVII

Enlace
Número 48. Junio 2024
Edita: Ilustre Colegio Oficial de Químicos de Madrid y Asociación de Químicos e Ingenieros Químicos de Madrid.
C/ Lagasca 27, 1.º E 28001 Madrid
Tel. 91 4 35 50 22
Fax 91 5 77 51 37 colquim@quimicosmadrid.org www.quimicosmadrid.org
Dirección: Lourdes Campanero
Campanero
Consejo de redacción: Íñigo Pérez-Baroja Verde
Lourdes Campanero Campanero
Emilio Gómez Castro
Valentín González García
Donato Herrera Muñoz
Tomás García Martín
Ángel Prieto Maeso
María del Mar Alarcón Hernández
Rosario García Giménez
Producción: Divulga S.L.
Coordinación: Ignacio Fernández Bayo Diseño y maquetación: José María Cerezo
Impresión: Editorial MIC ISSN: 2174-4653
Depósito Legal: M-26296-2011
Enlace no se hace responsable de los artículos firmados ni comparte necesariamente la opinión de los colaboradores.
La nanoquímica, la química de lo pequeño, busca entender cómo se comporta la materia a escala nanométrica e incluso inferior, en los dominios del ángstrom, la medida de los átomos. Las propiedades cambian, y esto hace que jugar con los nanomateriales posibilite un mundo infinito de aplicaciones. Después de cinco décadas de historia, la nanociencia tiene suficiente recorrido para tomar carrerilla y seguir conquistando parcelas en energía, medio ambiente, salud, informática, industria química y nuevos materiales (más allá del ya célebre grafeno). Para conseguirlo hacen falta tecnologías de vanguardia, que lleguen donde la vista y la habilidad humana no pueden, capaces de visualizar la estructura íntima de las moléculas y el proceso de las reacciones químicas paso a paso, en lapsos de tiempos increíblemente cortos.
Tecnologías cada vez más sofisticadas nos permiten estudiar la materia y sus transformaciones en espacios y tiempos ínfimos
Texto: Patricia Ruiz Guevara, periodista de ciencia y tecnología
Al fondo hay sitio, tituló el Nobel de Física Richard Feynman una célebre conferencia pronunciada en 1956 y que se considera el punto de arranque de la nanociencia, la nanoquímica y la nanotecnología. Su desarrollo desde entonces ha sido imparable y cada vez están más presentes en nuestra vida, aunque sea de forma inapreciable. Llevan el prefijo nano (que significa dividir una unidad entre mil millones) porque son disciplinas que trabajan a escala nanométrica; es decir, a la mil millonésima parte de un metro. La nanociencia, que surgió hace medio siglo, estudia los fenómenos físicos y la nanoquímica, la síntesis y las propiedades; ambas a escala nanométrica. La nanotecnología diseña, crea y manipula objetos y estructuras que están entre los 1 y los 100 nanómetros.
Si los avances son espectaculares en el ámbito del espacio más diminuto, también se producen en el del tiempo, gracias a tecnologías que permiten estu-
diar instantes tan minúsculos como un femtosegundo (una milbillonésima de segundo), escala en la que se trabaja ya
desde hace varios años y que permite visualizar una reacción química peldaño a peldaño; e incluso un attosegundo (tri-

llonésima de segundo). El Nobel de Física 2023 reconoció, precisamente, el desarrollo de esta última tecnología, que permite captar incluso el salto de un electrón entre diferentes niveles de energía en el átomo.
Nanotecnología cotidiana
“Cuando irrumpe una tecnología, el subidón se da en un periodo de tiempo relativamente corto. Así sucedió con la nanotecnología (a principios de los años 90 aproximadamente) y con la nanoquímica cuando eclosionaron”, cuenta Eva Pellicer, catedrática del Departamento de Física de la Universidad de Barcelona. En ese momento se incrementó la financiación de proyectos en este campo, el número de investigadores que invertían esfuerzos en ello y su presencia en los medios de comunicación, detalla la investigadora. La burbuja no pinchó, las expectativas se gestionaron bien y se apostó por

la inversión. “Si bien es cierto que llegar a un producto final requiere tiempo e inversión, sobre todo si pensamos en aplicaciones biomédicas (por ejemplo, nanoplataformas de liberación controlada de fármacos), algunas herramientas nanotecnológicas han llegado al mercado en un plazo de tiempo razonable, cosa que ha ayudado a incrementar la confianza de la sociedad y del usuario final en estas tecnologías”, considera Pellicer.
En este tiempo, la financiación no ha parado, como recuerda la experta, que menciona el caso de Estados Unidos, con la Iniciativa Nacional en Nanotec-
nología, lanzada en el año 2000 y punto de coordinación y colaboración para las agencias federales americanas que investigan en nanotecnología, o las numerosas convocatorias de proyectos de la Comisión Europa, que considera a la nanotecnología una “tecnología facilitadora esencial”. Y ahí seguimos.
Ya existen muchos productos en el mercado que incorporan nanotecnología. Según recoge la base de datos del sitio web StatNano, más de 11.000 a nivel mundial. Los hay en todos los sectores, pero encabezan la lista los de electrónica, medicina, construcción y cosmética, seguidos de textil, cosas del hogar, automoción y alimentación. “También se indican los compuestos o composiciones químicas principales que se emplean en los productos (óxido de silicio, óxido de titanio, plata, grafeno, nanotubo de carbono, óxido de zinc”, explica Pellicer.
Solo en Europa, el observatorio ubicado en Dinamarca, The Nanodatabase, recoge 5.367 productos que incluyen nanotecnología. Pero, según la experta, más importante aún es cómo se ha traducido en la creación de nuevos empleos y cómo su contribución al PIB mundial ha ido aumentando con los años.
Para analizar qué pasa a escala tan pequeña, desarrollar objetos con nuevas propiedades y conseguir estas buenas cifras, hacen falta técnicas e instrumentos para investigar; un equipamiento que mejora y evoluciona cada día. Lo confirma José Ángel Martín Gago, profesor de investigación del CSIC en el instituto de Ciencia de Materiales de Madrid (ICMM), que dirige el grupo de investigación ESISNA, en el que se estudian problemas interdisciplinares mediante técnicas de nanociencia y nanotecnología.
“Las técnicas que se usan son todas aquellas que nos permiten obtener información de objetos de tamaño nanométrico. Es decir, que tienen que tener una sensibilidad muy alta para poder identificarlos. Además, deben ser capaces de 'contarnos' cuáles son las propiedades nuevas que tienen esos objetos, propiedades que son consecuencia de su reducido tamaño y que hacen que puedan usarse en nuevas aplicaciones”, detalla.
La primera herramienta importante fueron los llamados microscopios de campo cercano (STM, AFM), según Martín Gago, que supusieron una revolución: “Para que nos hagamos una idea de su poder de amplificación, ver y
manipular un átomo es como estar sentado en la luna y ser capaces de ver y apretar cada uno de los tornillos de la Torre Eiffel desde allí”. Por otra parte, la radiación sincrotrón (aceleradores destinados a la producción de radiación electromagnética de alta intensidad, como Alba en Barcelona) “también son de una gran utilidad debido a que, gracias a la alta intensidad de la radiación generada por estas grandes máquinas, se consigue obtener información de objetos muy pequeños, de pocos átomos”. Son dos técnicas complementarias, con la primera vemos espacialmente el objeto y con la segunda aprendemos sobre sus propiedades.
Microscopías e instrumentación De nanotécnicas también saben en el Laboratorio de Microscopías Avanzadas (LMA), nodo de una Instalación Científico Técnica Singular (ICTS) de España.

El centro es titularidad de la Universidad de Zaragoza y está vinculado al Instituto mixto CSIC-Universidad de Zaragoza de Nanociencia y Materiales de Aragón (INMA), un centro Severo Ochoa. Allí investiga Pilar Cea, directora del LMA y catedrática de Química Física.
“Entre la instrumentación más singular y vanguardista del LMA destaca la microscopía de transmisión electrónica (TEM), donde contamos con tres microscopios de alta resolución, uno de ellos corregido en la lente condensadora y otro en la lente objetivo”, detalla Cea. Además, cuentan con equipos que permiten hacer simultáneamente nanofa-
Imágenes de una trillonésima de segundo
Si nos cuesta imaginar cómo sería ver lo diminuto, aún más difícil es intentar entender una unidad de tiempo ínfima. El attosegundo (trillonésima parte de un segundo) es la escala de tiempo más breve captada por el ser humano. Unido a esto, la attociencia es la especialidad que estudia los fenómenos que ocurren a esa escala y trata de encontrar maneras de observarlos en tiempo real.
A un instante mil veces más largo, en el dominio de la milbillonésima de segundo (o femtosegundo) hace tiempo ya que se trabaja en los laboratorios con cierta normalidad, pero medir o fotografiar en attosegundos es complejísimo. Ha sido posible mediante el desarrollo de herramientas sofisticadas, que les valió en 2023 el Nobel de Física a Anne L’Huillier, Pierre Agostini y a Ferenc Krausz. Sus contribuciones han permitido investigar procesos como el movimiento de los electrones o sus saltos de nivel de energía; procesos tan increíblemente rápidos que hasta hace poco era imposible seguirlos.
Son tecnologías experimentales, pero, como valoraron desde el comité del Nobel de Física, abren una puerta para comprender los mecanismos por los que se rigen los electrones y, a la postre, para ser capaces de utilizarlos, por ejemplo, en electrónica o en diagnóstico médico. En general, aplicar pulsos de luz con esa duración tan pequeña puede tener importantes aplicaciones en el avance

científico, en particular de la química.
En el grupo de Attociencia y Óptica Ultra-rápida del Instituto de Ciencias Fotónicas (ICFO) de Barcelona también exploran el mundo molecular a esa escala. Ya en 2016, en colaboración con investigadores de varios países, científicos de este grupo consiguieron una imagen nunca antes vista: la ruptura de un enlace molecular de acetileno nueve femtosegundos después de su ionización. Un visto y no visto en los límites de la física y la química.
“Fuimos capaces de obtener imágenes de la estructura de una sola molécula con un solo electrón, es decir, localizamos con precisión la ubicación de los átomos que hacen que una molécula sea una molécula”, cuenta el investigador principal del estudio y jefe del grupo de Attociencia y Óptica Ultra-rápida, Jens Biegert. “Es más, incluso podíamos seguir a estos átomos en tiempo real mientras se iba a producir la rotura de la molécula”, añade.

Reacción química registrada en el IFCO mediante espectroscopía de rayos X de attosegundos.
bricación y caracterización gracias al uso combinado de haces de iones y electrones, los llamados Dual-Beam. Otro tipo de microscopios y técnicas
Para ello, fabricaron una fuente de láser ultrarrápido en el infrarrojo medio combinada con un microscopio de reacción para detectar los momentos de distribución en 3D de electrones e iones en plena coincidencia cinemática. El objetivo: ver. “Si no se observa en qué configuraciones o estados se encuentra una molécula, ¿cómo se puede llegar a entender algo y posiblemente controlarlo? Si pudiéramos tomar muchas instantáneas durante una reacción química entenderíamos cómo funcionan realmente a un nivel fundamental”, explica Biegert.
Hacer esto es importante porque te asegura conocer cuál va a ser el resultado de una reacción, ahorra energía y permite fabricar nuevas sustancias. “Alrededor del 20% del presupuesto energético mundial se destina a la síntesis química. Si ahorramos un pequeño porcentaje, imaginemos su impacto medioambiental”, dice el investigador. Por el otro lado, “las empresas farmacéuticas gastan una fortuna para asegurarse de que las reacciones químicas producen lo que creen que están fabricando y no contiene residuos o sustancias tóxicas, con ejemplos dramáticos como la tragedia de la talidomida en Alemania”, que hizo que nacieran niños con graves malformaciones.
En este grupo del ICFO han seguido investigando a escala atómica y acaban de publicar un artículo en el que complementan el trabajo de imagen con espectroscopia de rayos X de attosegundos en tiempo real. “Esto nos permite comprender a nivel cuántico cómo una molécula en anillo se abre. Ahora contamos con nuevas y potentes herramientas que nos permiten estudiar problemas fundamentales y aplicados de la síntesis química”, afirma Biegert. Q
fundamentales son los de efecto túnel (STM), la microscopía de barrido electrónica (SEM), microscopía de fuerza atómica (AFM), la espectroscopia foto-
electrónica de rayos X (XPS) o la espectroscopia de pérdida de energía de electrón (EELS), enumera Cea. Un montón de infraestructuras para la observación,
caracterización, nanoestructuración y manipulación de materiales a escala atómica y molecular que el LMA pone a disposición de toda la comunidad científica e industrial, asegura la directora.
Son tecnologías complejas, pero aún queda mucho por desarrollar y así debe ser para que la nanociencia siga avanzando, considera Cea: “La utilización de equipamiento capaz de caracterizar los materiales en la escala más íntima de su naturaleza es absolutamente crítico para el desarrollo químico inteligente de materiales nanoestructurados capaces de revolucionar campos como el de la salud, la sostenibilidad o las tecnologías de la información y las comunicaciones”. A esta revolución nos encaminamos.
Ya conocen las técnicas, ahora les contaremos las aplicaciones.
El imán más fino del mundo
En Ant-Man (el hombre hormiga), el superhéroe protagonista se reduce a sí mismo hasta el tamaño mínimo de un

insecto. En el INMA, el instituto mixto del Consejo Superior de Investigaciones Científicas (CSIC) y la Universidad de Zaragoza (UNIZAR), han hecho algo parecido pero con un imán.
Después de siete años de estudio, un
De las energías renovables a la electrónica
Hay muchas más aplicaciones de la nanotecnología, actuales y posibles. En el campo del medio ambiente y las energías renovables, Rosalía Poyato sugiere mejorar la eficiencia de muchos sistemas gracias al uso de nanomateriales, por ejemplo, en el caso de las celdas de combustible o las baterías al incorporar catalizadores nanoestructurados. “También se pueden mejorar las técnicas de diagnóstico de imagen, como la resonancia magnética o la tomografía computerizada de rayos X (TAC), mediante la utilización de nanopartículas que actúan como agentes de contraste, y para la liberación controlada de fármacos”, agrega.
Martín Gago piensa en la utilización de nanopartículas como “verdaderos robots, transportadores de fármacos dentro del cuerpo humano, con todas las posibilidades que esto abre para diagnóstico precoz o para tratar enfermedades de manera no invasiva”. Por su parte, Pellicer menciona “la síntesis de catalizadores a escala nanométrica como, por ejemplo, nanopartículas soportadas en matrices porosas para la producción de hidrógeno a partir de agua”.
Pilar Cea piensa en la industria fotovoltaica y el desarrollo de nuevos materiales funcionales, o en el de materiales termoeléctricos para la conversión de energía térmica. “La relación entre sus propiedades de conductividad eléctrica y térmica está íntimamente relacionada con sus propiedades estructurales a escala nanoscópica”, recuerda. En el sector de la electrónica y las tecnologías de la información, “las aplicaciones del grafeno (y otros materiales 2D) se extienden a la espintrónica, en la que se está
equipo internacional de investigadores de estos centros ha conseguido crear un imán duro de espesor atómico. “Hemos usado técnicas de ultra-alto vacío para sublimar los dos componentes de la red metalorgánica (los derivados de antraceno y los átomos de hierro), por lo que no se pueden usar solventes. La red se forma por autoensamblado sobre una superficie de oro, así que es un crecimiento tipo “de abajo a arriba (bottom-up growth)”, explica Jorge Lobo, uno de los artífices de este hito, científico del INMA e investigador del LMA, donde se usaron los microscopios de efecto túnel para el estudio. Como ventaja, esa red está compuesta de elementos materiales muy baratos (C, N, H y Fe) y se forma por autoensamblado, indica el investigador. Como desventaja, ”este logro no es escalable ni industrializable a día de hoy, porque la temperatura de Curie (la temperatura a la que la red metalorgánica es ferromagnética) es de aproximadamente 240ºC bajo cero, por lo que solo funcio-
explotando su altísima conductividad eléctrica y propiedades topológicas para numerosas aplicaciones, como transistores de espín, y se están diseñando redes de nano-osciladores de torque de espín aplicados a redes neuronales”.
Diaz-Marcos hace referencia a los puntos cuánticos (quantum dots), protagonistas del Premio Nobel de Química de 2023 por sus propiedades fascinantes. “Gracias a los puntos cuánticos y su propiedad de fotoluminiscencia controlada en función de su tamaño, obtenemos una alta calidad de iluminación que puede ser usada en diversas aplicaciones, como los monitores de computadora y pantallas de televisión basados en la tecnología QLED, así como en bioquímica y biomedicina para cartografiar tejido biológico”, explica. Q


naría usando helio líquido”.
Desventaja entre comillas, porque ni mucho menos significa que el experimento sea un fracaso. “Nuestro objetivo era demostrar que una sola capa atómica con una proporción de tan solo 5 % de átomos separados a distancias de 1 nanómetro eran capaces de mostrar ferromagnetismo”, aclara Lobo. Objetivo conseguido.
Aunque las aplicaciones están todavía lejos, soñar con la nanoquímica sobre el papel es gratis, así que hagámoslo. Disponer de un imán así “permitiría fabricar dispositivos electrónicos más reducidos en grosor y tamaño; es decir, mejorar considerablemente la miniaturización y la integración; y reduciría la cantidad de material necesario en la fabricación, lo que redundaría en bajar los costes y reducir el impacto medioambiental”.
Si hablamos de cosas finas, hay que hablar de grafeno. Este material bidimensional (solo tiene un átomo de espesor) tiene simultáneamente propiedades mecánicas, eléctricas, ópticas y magnéticas. “Al grafeno se le ha llamado el material de Dios porque es un material que tiene muchísimas aplicaciones en campos muy diversos. Siendo tan solo de una capa atómica de espesor, es uno de los materiales más duros que se conocen, es transparente, flexible, conductor parcial de la electricidad y extremadamente ligero”, resume Martín Gago, del ICMM.
Este abanico de características mágicas es el motivo por el que se ha propuesto para aplicaciones en campos tan diversos como el energético, la construcción, la salud o la electrónica. Sin embargo, “la realidad es que todavía no hay demasiadas aplicaciones en cada uno de estos campos”, añade el investigador. Pero se sigue intentando. “Hoy día buscamos aplicaciones novedosas que sean capaces de transformar de manera disruptiva alguno de los dispositivos electrónicos o materiales que se usan en la tecnología actual, o construir nuevos dispositivos”. La Unión Europea ha hecho inversiones de miles de millones de euros para su investigación y ha puesto en marcha proyectos como el Programa Europeo Graphene Flagship. En la parte de la nanoquímica, Martín Gago explica que el grafeno es un material muy inerte y por tanto es muy difícil que haya química sobre él y completar un proceso de funcionalización química. “Uno de los retos importantes en el campo es conseguir acoplarle grupos moleculares

o nanoestructuras, tanto de forma covalente como no-covalente, sin que cambien las propiedades tan extraordinarias que posee. Sin embargo, este proceso es complicado y muchos grupos estamos trabajando en mejorarlo”, explica.
El grafeno no es el único investigado. Gracias a los trabajos de los últimos años, ha ido conociéndose mejor y se han empezado a buscar propiedades exóticas en otros materiales bidimensionales. “Se puede decir que el grafeno fue el primero de una gran familia, que
abrió las puertas al estudio de otros materiales en dos dimensiones”, dice Martín Gago. Así se han explorado capas de materiales semiconductores o aislantes (como el nitruro de boro hexagonal o los dicalcogenuros de metales de transición).
Además, en diversas aplicaciones se han comenzado a utilizar capas de diferentes materiales bidimensionales, de manera que cada una aporte sus propiedades particulares al conjunto. “Las técnicas que nos permiten obtener

información en la nanoescala han sido y son decisivas para comprender cuáles son las propiedades de estos materiales”, añade.
Cerámicas bidimensionales
Lo anterior es justo lo que hace Rosalía Poyato, científica titular en el Instituto de Ciencia de Materiales de Sevilla, cuya investigación se centra en el estudio de materiales cerámicos a los que se les añade una pequeña cantidad de un nanomaterial bidimensional, como el grafeno o el nitruro de boro 2D “de manera que podemos modificar las propiedades del material a gusto del consumidor”, explica.
“En los últimos diez años ha habido un interés creciente en la investigación de compuestos cerámicos con nanoestructuras laminares bidimensionales, traducido en un número creciente de publicaciones científicas y patentes”, indica Poyato. Gracias a estas investigaciones se están consiguiendo materiales que “presentan resistencia mecánica y tribológica más alta, y unas propiedades eléctricas y térmicas que pueden ser diseñadas a la carta, en función de la aplicación para la que se pretenda utilizar el material”.

microscopía electrónica de barrido en uno de los materiales en los que trabaja.
Para desarrollar estos compuestos utilizan la técnica de sinterización mediante corriente eléctrica pulsada, “una tecnología innovadora que permite la consolidación en tiempos muy cortos y con velocidades de calentamiento muy altas, de manera que se evita la degradación de las nanoestructuras”.
“Las nanoláminas de grafeno se colocan entre los granos de la cerámica, manteniendo su estructura bidimensional y una cierta rigidez. Aunque parezca que no hay muchas, las propiedades del material se alteran considerablemente tras introducir estas pequeñas cantidades de grafeno en la cerámica”, explica Poyato, como puede apreciarse en la imagen que muestra una
Aunque de momento los compuestos cerámico-grafeno no se están usando en la industria, en el futuro “podrán utilizarse en aplicaciones tecnológicas asociadas a condiciones de trabajo severas, como componentes para motores, microturbinas o microrrotores; en sistemas micro y nanoelectro-

mecánicos, sensores, actuadores e intercambiadores de calor; y como biomaterial en prótesis o implantes”, asegura Poyato.
Otra rama de la ciencia relacionada con los nanomateriales y la nanoquímica es la catálisis. “Mediante procesos catalíticos es posible conseguir nuevos productos a través de mecanismos de reacción alternativos, que no existirían sin la presencia de un catalizador. Gracias a ellos, es posible realizar procesos químicos seguros que permiten, por ejemplo, disminuir y transformar los compuestos contaminantes”, explica Cea, del LMA.
En el laboratorio participan en estudios para el desarrollo de procesos de alta eficiencia energética mediante el análisis de distintos tipos de catalizadores, basados en carbono (grafeno, nanotubos, óxido de grafeno), óxidos metálicos y nanopartículas metálicas (de metales nobles y de transición).
Otros compuestos a los que prestar atención son los materiales metalorgánicos estructurados. “El reciente descubrimiento y el alto impacto en la comunidad científica de la catálisis de átomos individuales ha supuesto la apertura de nuevas líneas de trabajo
Riesgos de la nanotecnología
Como con toda tecnología y desarrollo científico, hay que considerar el lado ético de su uso y sus posibles riesgos en la salud y el medio ambiente, que, a día de hoy, son inciertos. Para entender por qué, Diaz-Marcos dice que lo primero es remarcar que los nanomateriales “se han de tratar como otro producto químico, y como tal es más importante su dosis y toxicidad que su tamaño”. Partiendo de aquí, “muchos productos con nanomateriales se usan sin conocer completamente su impacto; aunque existen estudios toxicológicos, muchos tienen limitaciones”.
Los riesgos de exposición a los nanomateriales están asociados a su manipulación, fabricación y procesado. “Debido a su minúsculo tamaño, su potencial toxicidad puede venir de sus propiedades fisicoquímicas, de la posibilidad de que atraviese barreras biológicas del cuerpo humano (barrera hematoencefálica o la piel), de su forma, solubilidad, capacidad de reacción del nanomaterial o nanopartículas entre sí o con otras substancias, así como de factores que dependen de la forma de exposición, del tipo de producto y de la vía de entrada”, sintetiza Diaz-Marcos.
Las nanopartículas se pueden inhalar, ingerir y también pueden penetrar por la piel. Esto podría afectar a personas expuestas a ellos, por ejemplo, en un ambiente laboral. El verbo se usa en condicional porque, según los expertos, aún no hay información suficiente para afirmar si los nanomateriales son peligrosos o no, y existen pocas investigaciones sobre el daño a la salud por exposición laboral a nanomateriales en general. Pero sí es cierto que cada vez existen más productos en el mercado y, por tanto, cada vez estamos más expuestos a los nanomateriales. “Por lo tanto, es crucial mantenernos alerta, informados y aplicar el principio de precaución para proteger la salud y seguridad de los trabajadores expuestos a estos productos”, dice.
En lo que respecta al medio ambiente, “la exposición industrial y la contaminación ambiental se incrementan a medida que aumenta la producción de nanomateriales. De aquí que se haya acuñado el término ‘nanopolución’ ”, indica Pellicer. En general, la experta cree que “no hay que generar alarma social, pero sí que es cierto que los riesgos asociados al uso, ya sea controlado o incontrolado, de materiales a la nanoescala hay que estudiarlos bien y comprender su toxicología, para poderlos gestionar correctamente”. Q
para las que se necesitan equipos que sean capaces no solo de identificar esos centros activos, sino de caracterizarlos química y electrónicamente”, dice Cea. De nuevo, aquí juega un papel esencial la microscopía electrónica y la nanotecnología.
Impresión 3D con nanopartículas En la empresa de base tecnológica del CSIC COLFEED4Print S.L. unen nanociencia e impresión 3D. Su objetivo es aportar productos innovadores por extrusión térmica de dispositivos en aplicaciones como la regeneración de huesos y tejidos, el almacenamiento de energía, la manipulación de alimentos o en sistemas de depuración fotocatalítica, explica Pablo Ortega, responsable de Investigación y Desarrollo en Impresión de COLFEED4Print. Lo que ofrece su tecnología es incluir el uso de nanopartículas de composición compleja (nanomedicina, conductores iónicos, cocatalizadores y nanosensores) para mejorar el rendimiento de dispositivos tecnológicos, y hacerlo desde el prototipado y la fabricación. “Con nuestro proceso proponemos un nuevo acer-
camiento al desarrollo de materiales termoplásticos compuestos con una alta carga de partículas funcionales, que mejora la resolución de impresión y dota de propiedades específicas al producto final”, asegura Ortega.
Según indica, la tecnología de fabri-

Ana Pizarro.
cación de COLFEED4Print permite incorporar a la matriz polimérica partículas inorgánicas de diferente natu-
raleza (oro, plata, titanio, grafeno, hidroxiapatita, biovidrio), diferente tamaño (micro y nanopartículas) y diferente forma (fibras, placas). “Esto permite customizar y optimizar al máximo las funcionalidades médicas, energéticas o estructurales de las piezas finales impresas”, añade. Ahora mismo, están en fase semilla y presemilla, y siguen investigando.
Metalofármacos y nanopartículas
Al preguntar a varios de los expertos entrevistados por su uso favorito de la nanociencia, muchos respondieron (aunque no fuera su propia área de trabajo): las aplicaciones médicas. En el grupo de investigación de Metalofármacos, en IMDEA Nanociencia, utilizan nanotécnicas y desarrollos nanotecnológicos para mirar dentro de los procesos biológicos e investigar en medicina.
Los metalofármacos son entidades químicas moleculares, iones metálicos utilizados en medicina, tanto con fines diagnósticos como terapéuticos, que tienen un metal de transición en el centro. Puede ser rodio, iridio, osmio…, y están rodeados de una serie de átomos organizados en pequeños grupos, explica Ana Pizarro, jefa del grupo de investigación de Metalofármacos. Lo interesante es que “estos metalofármacos pueden mediar reacciones químicas dentro de la célula, y lo que hacemos es diseñarlos para que esas reacciones químicas sean específicas y podamos controlar cuándo se activan y cuándo no”.
A la hora de elegir los metales de transición que funcionan, “lo que hacemos es buscar una combinación que consiga un balance perfecto: necesitas que el compuesto sea reactivo, pero no mucho, porque ya tiene muchísimas cosas con las que reaccionar dentro de la célula”, explica Pizarro. “Vas probando y estudiando su reactividad, cómo reaccionan. Rutenio, osmio, platino, iridio y rodio son algunos con los que se puede trabajar”. Así, se pueden utilizar para “crear metabolitos que ayuden a la célula a defenderse contra el cáncer o pueden activar el sistema inmune a través de una interacción directa con alguna molécula”, añade. Ya hay metalofármacos que se usan, por ejemplo, de cobre, platino y vanadio, “aunque algunos tienen muy mala fama, como los citotóxicos, porque son muy agresivos con los tumores, pero también con las células
sanas”, pero en general se trata de una técnica en investigación.
“Ahora, todos nuestros esfuerzos están concentrados en entender a nivel molecular qué sucede dentro de la célula y controlar cómo nos puede afectar. Son compuestos muy peculiares que son capaces de ejecutar químicas únicas, pero para explotarlos en biomedicina
lado industrial es un reto pendiente en la mayoría de los casos. “Cuanto más complejo es el nanomaterial, más complejo se vuelve su escalado y su implementación en dispositivos”, señala Pellicer. Sí hay historias de éxito; por ejemplo, de empresas españolas como Endor Nanotechnologies, que “han conseguido escalar la producción de nano-

primero hay que comprenderlos; nos falta subir ese escalón y encontrar la diana molecular”, indica Pizarro. Gracias a la nanotecnología, lo hacen utilizando técnicas supervanguardistas.
“Cuando estos compuestos median reacciones químicas suceden una serie de cambios muy pequeños en torno al núcleo metálico. Utilizamos mucha instrumentación nanoscópica para poder encontrar este compuesto dentro de nuestra célula, controlar la reactividad química y técnicas de imagen para poder ver los compuestos dentro de la célula”, explica la investigadora.
Por otro lado, también hay nanopartículas que se pueden utilizar con distintas funciones para atacar a las células cancerosas, algo sobre lo que también se investiga en IMDEA Nanociencia con proyectos como el NoCanTher, un proyecto europeo que prueba nanopartículas magnéticas para hipertermia contra el cáncer de páncreas.
Los expertos y expertas coinciden en que la aceptación de la nanotecnología es bastante buena, mientras que el esca-

partículas para aplicaciones en cosmética o biomedicina, como es el caso de nanopartículas de oro de 10 nanómetros de diámetro recubiertas de ácido hialurónico para aplicaciones de cremas antiedad”, indica la investigadora. Aunque cuando hablemos de nanociencia pensemos en pequeño, en realidad se trata de una disciplina que nos
permite soñar a lo grande. “Adentrarse en el nanomundo es algo fascinante desde una perspectiva científica, ya que permite reexplorar los principios fundamentales de la física y la química en la nanoescala”, se maravilla Poyato. Y aplica a todo lo que pensamos, también a lo más lejano y grande, como las estrellas. “Las nebulosas que existen en el espacio no son más que nubes de polvo de tamaño nanométrico y gas (moléculas). Algo así como nanociencia en acción. Las interacciones entre ellas dan lugar a la complejidad química en el universo, y pueden estudiarse perfectamente mediante técnicas de nanociencia”, explica Martín Gago, que investiga en el proyecto ERC-Synergy para construir instrumentación que permita simular en laboratorio la formación del polvo interestelar y sus procesos químicos.
Eso si miramos hacia el cielo; si miramos a futuro, “en el sector médico tendremos decenas de tratamientos basados en nanopartículas para todo tipo de enfermedades en 20 o 30 años”, predice Jordi Diaz-Marcos, coordinador de la unidad de Técnicas Nanométricas de los centros científicos y tecnológicos de la Universidad de Barcelona (CCiTUB) y de la unidad de divulgación de las nanotecnologías, Nanodivulga UB. También para detección: “Con una gota de sangre, un tatuaje con grafeno o una lente, podremos tener monitorizados nuestros principales parámetros sanguíneos y tener un seguimiento a tiempo real de parámetros clave”. También habrá aplicaciones en el campo de la energía, el grafeno mejorará las baterías y tendremos nuevos sistemas de filtración y potabilización gracias a la nanotecnología, que serán clave para paliar la escasez de agua, sugiere. En el horizonte también se ve venir “la incorporación de la inteligencia artificial y el aprendizaje automático a microscopias y espectroscopias, que puede llevarnos en poco tiempo a un salto abismal en el desarrollo de nueva instrumentación y software asociado para tratamiento e interpretación de los datos recogidos”, cree Cea. Por ejemplo, en neurociencia, “encontrar materiales que puedan actuar como sinapsis de futuras redes neuronales autoensambladas es otro campo de investigación muy activo en estos momentos que puede llevarnos a destinos insospechados”. La promesa de la nanotecnología y la nanoquímica no pinchó; está más viva que nunca. Q
Juana Bellanato Fontecha (Madrid, 1925) ha pasado una vida entera dedicada al campo de la espectroscopía. Estudió ciencias químicas en la Universidad Central de Madrid (hoy, Complutense) y pasó al entonces recién fundado Instituto de Óptica Daza de Valdés (CSIC) para hacer la tesis. Empezó como becaria, luego colaboradora, investigadora y profesora de investigación. En 1975 fue nombrada encargada de la Sección de Espectros Moleculares y del Laboratorio de Espectroscopia Molecular, y en 1979 jefa de la Unidad de Espectros Moleculares. Se jubiló en 1990 pero continuó vinculada, como doctora ad honorem hasta diciembre de 2007. Además, presidió el Comité Español de Espectroscopía y el Grupo Español de Espectroscopía. Su trabajo se ha desarrollado en el campo de la espectroscopia infrarroja y Raman aplicada en química orgánica, medicina, farmacología e industria. Casi centenaria, es un testimonio vivo de la evolución de la química española en el siglo XX.
Entrevista a Juana Bellanato Fontecha, química experta en espectroscopía
“Creo que he hecho bastante bien a la gente en el sentido científico”

Pregunta. Fue muy buena estudiante y consiguió varias becas, ¿por qué eligió la química? Respuesta. En el bachillerato me dieron premio extraordinario y matrícula de honor, pero luego ya fueron bajando las notas porque, además, tenía que trabajar dando clases particulares para ayudar a la familia. Elegí química porque me gus-
taba, porque a mi padre le gustaba, y porque en el bachillerato, cuando la gente empezaba a fracasar en química, yo era muy buena. Como sacaba tan buenas notas todo el mundo me preguntaba si estudiaría química. A mi padre le gustaba cacharrear con cosas que tuvieran que ver con la química, así que, aunque me gustaban también las letras, no lo dudé.
P. Estudió entre 1944 y 1949, ¿cómo era entonces la facultad?
R. No tengo malos recuerdos de la facultad. En primero saqué muy buenas notas, tuve dos becas lo que me daba un poco de remordimiento. Una de ellas era de 500 pesetas al mes. Si eres creyente sabes que todo en la vida es providencial. Al terminar la carrera entonces sí que estaba difícil para las mujeres encontrar empleo. Fui a un laboratorio donde había trabajo, pero era para gente con bachillerato, no para una licenciada. Yo les decía que no me importaba trabajar como auxiliar de laboratorio, pero nada. P. ¿Y cómo consiguió empleo?
R. Una hermana mía se encontró al profesor de química de nuestro instituto, el Isabel la Católica, y él le preguntó por mí; ella le contó que estaba buscando trabajo y él le dijo que fuera a verle. Trabajaba a media jornada en el Instituto de Óptica, recién inaugurado y aún no había mucha gente. Fui a verle y me quedé allí como becaria sin beca y pronto pasé a colaboradora eventual. Creo que no se lo he agradecido suficientemente. Todos a mi alrededor estaban organizando mi destino y yo no me daba cuenta, sólo quería trabajar. Él había estado un año en Norteamérica formándose en espectroscopía IR, así que empecé la tesis con él, en espectroscopía infrarroja de aminas primarias, que defendí en 1954, y continué en el Instituto de Óptica.
P. ¿Cuándo entró de becaria había más mujeres, además de usted?
R. Sí, yo no fui la primera. Era la primera en la Sección de Espectros Moleculares, que estaba incluida en el Departamento de Espectroscopía, que dirigía el profesor Miguel Antonio Catalán, y él tenía ya mujeres. Procedía de la Institución Libre de Enseñanza, no iba a ser machista. Y luego estaba también la sección de Fotografía y Fotoquímica, que dirigía María Teresa Vigón, que era hija del general Vigón. Muchas mujeres preferían hacer la tesis en los pocos departamentos donde la directora fuese mujer.
P. ¿En sus estancias en el extranjero la situación era parecida?
R. Aquí había pocas mujeres que habían estudiado y estaban en la universidad, pero en Friburgo y en Oxford era lo mismo. En el Instituto de Física Química al que yo fui resulta que solo había una universitaria, Barbara Stark. Y en Inglaterra, las únicas mujeres éramos yo y una polaca, el resto eran hombres.
P. ¿Qué le atrajo de la espectroscopía? Es una parte central de la química, de
la estructura de la materia, con aplicaciones en química analítica, orgánica, inorgánica...
R. Yo soy bastante polifacética en este sentido. Todo mi trabajo ha sido de colaboración con otros investigadores: los químicos orgánicos sintetizan, por ejemplo, productos farmacéuticos, y tienen que recurrir a técnicas auxiliares espectroscópicas: de rayos X, de resonancia magnética nuclear, infrarroja, Raman...
P. Usted se especializó en espectroscopía infrarroja y Raman ¿verdad?
R. Sí, aunque Raman menos. Ambas son técnicas complementarias. En la actualidad Raman es fundamental porque hacen aparatos pequeñitos, que se pueden llevar a todas partes. Unos compañeros míos han estado ahora en Egipto bajando a las tumbas. Cada vez se necesitan más. Y lo mismo ocurre con los espectrógrafos IR.
CC Por entonces, las mujeres trabajaban al abrigo de los hombres, jefes, catedráticos, pero yo no sentí ninguna discriminación DD
P. Sus estudios con radiación infrarroja aplicada a diferentes estructuras moleculares han servido en la síntesis de compuestos orgánicos y para analizar alimentos (cerveza, lácteos, aceites, vinos…), microorganismos, estudios veterinarios, medicamentos, compuestos de distintos sectores industriales… R. Son muchos años de trabajo y me ha dado tiempo a trabajar en muchas cosas. Tengo casi 200 trabajos, casi todos en colaboración; sola fueron pocos. También he publicado un libro en colaboración y escrito capítulos para varios libros y dirigí una tesis. Colaboraba mucho porque se enteraban unos por otros y venían a pedirme ayuda de muchas áreas diferentes: investigadores de las universidades de Sevilla, Valencia, Murcia, Alcalá de Henares, la Complutense y la Autónoma de Madrid... Colaboré mucho, por ejemplo, con el grupo de química orgánica de la Facultad de Farmacia de la Complutense y también con los de Alcalá de Henares
y Sevilla. Otras veces eran científicos de otras áreas que venían a nuestro grupo a solucionar problemas y también estudiantes que estaban haciendo la tesis y no podían acabarla porque no estaba completa sin la parte espectroscópica. Y también de la industria de la alimentación, bebida, como la cerveza, fabricación del vidrio…
P. Especialmente trabajó en el estudio de cálculos biliares y renales, tanto en el cuerpo humano como en animales ¿no?
R. Sí. En veterinaria por espectroscopía infrarroja aplicada a cálculos de animales, sobre todo de perros y caballos. Y en medicina, llegó un médico de la Clínica de la Concepción, el doctor Cifuentes Delatte, y nos pidió ayuda para el análisis de cálculos sobre todo renales. Trabajé muchos años con él, fuimos juntos a varios congresos, en Davos, en Bonn, en Viena… y publicamos muchos trabajos en colaboración.
P. Trabajó desde ayudante de investigación hasta profesora de investigación. ¿Qué disfrutaba más?
R. Todo esto me permitía asistir a muchísimos congresos de mi especialidad con lo cual he viajado mucho; era la compensación. Estuve en la India, en Japón, en Norteamérica, en Europa, en la URSS... Gente de mi generación y posterior se metieron a trabajar en laboratorios, en la empresa, pero ahora tienen menos currículum que yo. Yo he tenido la suerte de estar en el CSIC. Entré de las primeras, y luego me fueron ascendiendo... Ahora que es tan difícil entrar en el Consejo, pues yo no tuve que hacer ningún examen ni oposición. Además, no sentí nunca ninguna discriminación por ser mujer.
P. También disfrutó de varias estancias en el extranjero, en Friburgo de Brisgovia y Oxford, y conoció a C.V. Raman, Nobel de Física 1930. ¿Encontró que el nivel científico era superior al de España?
R. El nivel de la gente era muy parecido, lo mismo en Alemania que en Inglaterra. En Friburgo estuve en el Institut für Physikalische Chemie 15 meses. Como estábamos aquí tan atrasados, tenían la idea de que al ser española iba a llegar con castañuelas y bailando. Se llevaron una desilusión. Fui allí sin experiencia, de la España de Franco a Alemania que estaban más adelantados que nosotros en costumbres y en todo, a pesar de que la guerra les dejó muy mal. En el Instituto había un servicio con ducha y la

gente se duchaba ahí, se ve que en su casa aún no tenía un cuarto de baño normales y la gente que trabajaba allí se duchaba gratis. En Inglaterra el director era Sir Cyril Norman Hinshelwood, que también ganó el Nobel. Durante mi estancia era la única mujer junto a una becaria polaca, el resto eran hombres.
P. Con la perspectiva que tiene, ¿cómo cree que ha cambiado la química en España y en el mundo?
R. Yo ahora prefiero no enterarme. Veo que mis compañeros tienen más medios porque todos los aparatos han ido mejorando mucho con el tiempo, ahora cada vez son más perfectos y con cantidades muy pequeñas se puede hacer un análisis. Hay aparatitos de infrarrojo en Marte. Ha avanzado todo mucho. He oído que un grupo ahora tiene un contrato con la Casa de
Lista de premios
1968 premio Perkin Elmer al mejor trabajo de Espectroscopia de Absorción junto a A. Hidalgo
1996 medalla de Plata del Comité Español de Espectroscopia
2002 medalla de plata de la Sociedad Española de Óptica
2003medalla de la Real Sociedad Española de Química
2006 premio Jesús Morcillo Rubio de la Reunión Nacional de Espectroscopia
2006 placa institucional del CSIC
la Moneda para aplicar la espectroscopía Raman para detectar la falsificación de billetes, o sea que, estas aplicaciones se han ido aumentando con el tiempo porque la técnica ha ido mejorando.
P. Pero cuando se iba a casa seguía dándole vueltas...
R. No, no. Yo tenía otras cosas que hacía por la tarde, corrección de libros, reuniones, me dediqué a traducir algunos libros, del alemán y francés al español... Yo no era un bicho raro de esos.
P. Le han dado un montón de premios, ¿qué han supuesto para su carrera?
R. Nada, pero me ha gustado mucho que me los den. El ultimo que me han dado es la placa de Colegiado Distinguido San Alberto 2023. Pienso también que a veces he hecho bastante bien a la gente en el sentido científico. Hay
muchos que han venido a pedirme ayuda, he colaborado y han llegado alto.
P. Estudió teología en la Universidad Pontificia de Comillas. No es frecuente compatibilizar ciencia y religión…
R. Siempre me preguntan por eso. Me lo sugirieron cuando estaba todavía trabajando y había un bachillerato de teología para gente ya con carrera; asistí a clase cinco años por las tardes. Al jubilarme y perder a mi madre y a una hermana, con las que convivía, me decidí a seguir y licenciarme. Al terminar, con la tesina ya hecha, colaboré muchos años con la Cátedra de Bioética, que está tan de moda desde hace unos años. Me propusieron hacer el doctorado, pero les dije que ya con mis años y siendo doctora, que ya no, con lo difícil que eran las tesis allí.
P. He leído que la relación con los hombres era buena en la facultad, pero que había cierta indiferencia hacia las mujeres.
2007 insignia de Oro y Brillantes de la Asociación de Químicos de Madrid ANQUE
2013 Reconocimiento Mayores Magníficos. Consejería de Asuntos Sociales. Comunidad de Madrid.
2013 medalla honorífica de la Cátedra de Bioética de la Universidad Pontificia de Comillas
2023 placa de Colegiado Distinguido San Alberto Q
R. Ahora es diferente, pero entonces, digamos, las mujeres trabajaban al abrigo de los hombres, jefes, catedráticos. Yo vi un poco de discriminación, de cierta preferencia del profesor por los alumnos hombres. En el Instituto de Óptica eran todos muy abiertos, pero en el Instituto de Química Orgánica, por ejemplo, las mujeres podían hacer la tesis, pero luego se tenían que marchar. En el Instituto Rocasolano había un investigador que decía que no quería mujeres en su laboratorio porque si eran guapas era una tentación y si eran feas no le apetecía. Esto lo he oído decir yo, hace muchos años. En mis tiempos, muchas mujeres venían de provincias porque no había universidades en todos sitios, entonces venían chicas muy listas, muy estudiosas, y los padres las mandaban a Madrid. Lo que pasaba es que se casaban, habían terminado la carrera y el marido no las dejaba trabajar. De las que yo conocía, algunas se dedicaron a la enseñanza al cabo de los años; otras, que quisieron dedicarse a la investigación, fracasaron...
P. El año pasado formó parte del Comité Internacional para la organización del Congreso Europeo de Espectroscopía Molecular (EUCMOS). ¿Sigue en activo a su edad?
R. Bueno, en la reunión de Coimbra, en 2018, dije que dimitía y me dijeron que no. Continué hasta la siguiente reunión, en Finlandia en 2023, en que me nombraron socia de honor junto a otros tres mayores. Así está bien. Q
El aceite de oliva es el que proviene del zumo de la aceituna, (Olea europaea L.), obtenido por procedimientos mecánicos o por otros medios físicos y químicos en unas condiciones que no provoquen alteraciones en el aceite. Se distinguen tres tipos, según su calidad: Aceite de Oliva Virgen Extra, de calidad superior, obtenido del zumo de aceituna sana solo por procedimientos mecánicos y que no ha tenido más tratamiento que lavado, batido, decantación, centrifugación y filtrado. Tiene características organolépticas irreprochables. Aceite de oliva Virgen, cuyas características organolépticas no son ya excepcionales y puede tener algún defecto. Aceite de Oliva, que proviene de un aceite defectuoso que ha sido refinado por procesos químicos y térmicos y se ha enriquecido después con aceite de oliva virgen o virgen extra. Carece de gran parte de los compuestos orgánicos y antioxidantes naturales presentes en los aceites de mayor calidad.
Texto: Dolores Jaén Cañadas, licenciada en Ciencias Químicas, doctora en Seguridad Alimentaria y directora de Laboratorios Higea.
De todos los aceites de oliva en el mercado, el Aceite de Oliva Virgen Extra (AOVE) es el más saludable y beneficioso debido a la cantidad de los compuestos bioactivos, que bien podemos denominar guardianes de la salud, presentes en él. El AOVE es rico en antioxidantes, lo que significa que puede ayudar a proteger las células del estrés oxidativo y reducir el riesgo de enfermedades crónicas. También es especial por su riqueza en ácido oleico, a diferencia de los demás aceites vegetales, lo que le otorga mayor capacidad de resistencia a la oxidación.
Dentro de su composición química nos encontramos dos fracciones; una que ocupa del 97 al 99% de su totalidad, que es la fracción saponificable formada por triacilglicéridos (TAG), y una pequeña fracción insaponificable, formada por ácidos grasos libres, que son los que le confieren estabilidad, generan sus características organolépticas de amargo y picante y todas las propiedades saludables, nutricionalmente hablando, virtudes que se pierden en el proceso
de refinado. En esta fracción insaponificable es donde se encuentran los guardianes de la salud como son:
El β caroteno, que es un pigmento responsable, junto con la clorofila, de la coloración verde y amarillenta del aceite. Es el precursor de la vitamina A y del licopeno, que son considerados antioxidantes.
Los esteroles y fitosteroles, entre ellos el β sitosterol, que tienen una función estructural. Destacan por su capacidad como hipolipemiantes, al competir con el colesterol e interferir su absorción intestinal.
El tocoferol o alfatocoferol, más conocido como vitamina E, es un potente antioxidante. Es el componente mayoritario (95 %) biológicamente activo y en el AOVE hay una cantidad de 150 a 200 mg/Kg. Con unos 50 gramos de AOVE al día nos estaríamos tomando el 100 % de la cantidad diaria recomendada.
El escualeno, que es el principal hidrocarburo, producto intermedio de la biosíntesis del colesterol, al que se le ha atribuido una baja incidencia cancerígena.


Compuestos fenólicos, un conjunto de compuestos complejos, responsables de los aromas y sabores del AOVE. Dentro de este grupo se encuentran:
n El hidroxitirosol (HT), que es un compuesto fenólico que se encuentra en pequeñas cantidades en determinados alimentos, especialmente en los de origen mediterráneo. Se considera que tiene una fuerte acción antioxidante, de manera que protege a las células del daño que los radicales libres pueden causarle. Esto ayuda a que nuestras células se mantengan en buen estado durante más tiempo, más rejuvenecidas y libres de posibles enfermedades crónicas. Es uno de los beneficios que siempre se han señalado del aceite de oliva virgen extra.
n La oleuropeína, que ofrece cierta protección cardiovascular, ya que es capaz de reducir la presión arterial, según un estudio publicado por Oncotarget, y ayuda a aumentar el flujo sanguíneo y a mejorar la función arterial. Varios estudios la han relacionado con la prevención del daño oxidativo en el cerebro, reduciendo el riesgo de algunas enfermedades neurodegenerativas, como el parkinson y el alzheimer. Tiene un efecto antimicrobiano, por lo que también se ha usado para combatir algunas infecciones. Además, ayuda a mantener el sistema cardiovascular en las mejores condiciones. Se ha estudiado

su administración mediante inyecciones, y los resultados han sido evidentes: es capaz de reducir tanto la presión arterial sistólica como la diástolica en diferentes especies animales. Al parecer, actúa protegiendo al hipotálamo del estrés oxidativo, y mejora la función mitocondrial. n El oleocantal es uno de los compuestos más reconocidos del aceite de oliva virgen extra. Fue descubierto por Gary Beauchamp durante un experimento para mejorar el gusto del ibuprofeno. Es un potente antiinflamatorio que inhibe la encima cyclooxigenasa, de la misma manera que el ibuprofeno, protege del cáncer, ya que tiene un efecto antiproliferativo de las células tumorales, y de las enfermedades neurodegenerativas.
También nos encontramos numerosos compuestos volátiles y aromáticos, que son de muy diferente naturaleza y que dan al aceite de oliva fragancia y sabor, como hidrocarburos, fenoles, cetonas, ésteres, terpenos, alcoholes, aldehídos… Su cantidad y composición varían en cada aceite según su frescura y calidad, variedad y las condiciones edafoclimáticas del olivo.
Muchos estudios científicos han demostrado las propiedades saludables del AOVE, que forma parte de la dieta mediterránea en general, que es rica en ácidos grasos monoinsaturados y baja en ácidos grasos saturados. El
aceite de oliva virgen extra es cardioprotector y la única grasa que baja el colesterol total, reduce el LDL (conocido como colesterol malo), previene su oxidación y aumenta el HDL, o colesterol bueno, por lo que reduce la presión arterial.
Además, disminuye la acidez estomacal; tiene un efecto saciante; aumenta la secreción de la lipasa pancreática, que permite digerir las grasas; y mejora la digestión de los lípidos evitando la absorción del colesterol por la vesícula biliar. Con todos estos guardianes de la salud, compuestos bioactivos que contiene, se ha logrado cambiar la pirámide de la dieta mediterránea y colocar el AOVE en el centro de la misma.
El aceite de oliva virgen extra es un alimento saludable que debe ser incorporado a una dieta equilibrada y rica en nutrientes. Sus compuestos bioactivos pueden ayudar a proteger contra enfermedades crónicas y mejorar la salud general, ya que tiene funciones antioxidantes, anticancerígenas, cardioprotectoras, antiinflamatorias y neuroprotectoras. Sin embargo, es importante recordar que la calidad del aceite es fundamental para aprovechar al máximo sus beneficios. Es importante elegir aceites certificados como Aceite de Oliva Virgen Extra para asegurarse de que contengan los niveles adecuados de compuestos bioactivos. Q
Para muchos químicos la vocación nació en los laboratorios del colegio o el instituto, cuando se ponía en práctica lo que se estudiaba teóricamente en clase. Cacharrear y experimentar despierta la curiosidad en los alumnos y produce con frecuencia asombro y decide vocaciones. No importa que sean los mismos experimentos que se realizan en la mayor parte de los centros y que se repitan cada año. Pero también existe la opción de ir más allá y retar a los alumnos a conseguir una meta más audaz: desarrollar ellos mismos un proyecto de investigación propio y novedoso. Y hacerlo desde el principio, diseñando un objetivo, una metodología y una planificación, buscando y recopilando la bibliografía que pueda haber en torno al tema elegido, llevando a cabo el proceso de investigación, tanto teórico como práctico, y plasmando los resultados hasta elaborar unas conclusiones. E incluso convertir el trabajo en un paper que pueda ser publicable.
La idea de incorporar la excelencia a la enseñanza de los últimos años previos a la universidad nació en el seno del Colegio y la Asociación de Químicos de Madrid, que decidieron en 2023 poner en marcha un concurso, bajo el nombre Química con Excelencia, para alumnos y alumnas de segundo de bachillerato que intentaran llevar adelante un proyecto de investigación completo. “Para ver la viabilidad de la idea
concurso desde la Junta Directiva del Colegio y la Asociación, “son tres principalmente: promover el interés de los estudiantes por la ciencia (y en especial la química); impulsar las relaciones de nuestras instituciones con los centros educativos; y, el principal, colaborar en la mejor formación de los estudiantes para que aprendan a trabajar en proyectos y en colaboración entre ellos y con la comunidad científica”.

y como experiencia piloto invitamos a presentarse a los 13 institutos considerados de excelencia en la Comunidad de Madrid, que ya trabajan incorporando en sus centros la realización de proyectos”, dice Íñigo Pérez-Baroja Verde, decano-presidente del Colegio y la Asociación.
Texto y fotos: Ignacio Fernández Bayo, periodista de ciencia
Los objetivos son múltiples. Según Emilio Gómez Castro, profesor de la Facultad de Ciencias Químicas de la Universidad Complutense y uno de los impulsores del
Cuatro de esos centros respondieron positivamente y presentaron sus proyectos. Tras la reunión del jurado, se proclamó como ganador el denominado “Nueva generación de antibióticos basados en compuestos organometálicos: una respuesta a la aparición de bacterias resistentes”, desarrollado por Yago Martínez y Alejandro Font bajo la supervisión de su profesora Marta Morán Bayón, del IES El Burgo-Ignacio Echeverría, de Las Rozas, Madrid.

Todo empezó de forma casual: “entré en Instagram y vi en una de las cuentas que sigo que había puesto un enlace a un concurso. Solo faltaban dos días para que se cerrara la presentación de proyectos y hablé con Alejandro para proponerle que nos presentáramos juntos y con Marta, mi tutora. Por suerte teníamos ya la idea del tema”, explica Yago Martínez. Los estudiantes se plantearon la posibilidad de desarrollar un MOF (estructuras híbridas con una parte orgánica y otra metálica) que pudiese cumplir una función antimicrobiana, ante el creciente problema de las resistencias ante los antibióticos desarrolladas por numerosas bacterias, lo que se está convirtiendo en un problema grave de salud pública. “Conocía el problema de la resistencia a los antibióticos porque una tía mía tuvo una infección que le provocó una sepsis general y estuvo hospitalizada. Luego contacté con una investigadora del CSIC que trabajaba con polímeros metalorgánicos y así empezamos”, añade.
Según explican, dedicaron buena parte de su tiempo libre a lo largo de siete u ocho meses a su trabajo. “Al principio queríamos hacer algo más práctico y sintetizar el MOF, pero el experimento no salió como esperábamos”, dice Alejandro Font. El problema fue, según explican, “que echamos demasiada agua y en lugar de obtener los cristales esperados nos salió una masa acuosa. Y como no teníamos recursos para volver a hacer el experimento decidimos centrarnos en el desarrollo de un MOF hipotético, que teóricamente debería funcionar”.
Ahora, su propósito es tratar de que se lleve a la práctica a través de algún centro de investigación y tienen previsto hablar con la Real Sociedad Española de Química para conseguirlo. De momento, han convertido su proyecto en un paper que también tratarán de publicar. Y de
cara a su futuro personal y profesional, Alejandro aún tiene dudas sobre la carrera que cursará, “quiero hacer Medicina, pero no sé si me dará la nota”. Por su parte Yago lo tiene claro: “quiero estudiar química; por ejemplo, de materiales o bioquímica, y dedicarme a la investigación. Me parece bastante divertido“.
El acto de entrega del premio tuvo lugar en el IES El Burgo-Ignacio Echeverría el pasado 23 de mayo. Tras la bienvenida pronunciada por la directora del centro, Ana Isabel Crespo Cuenca, Íñigo PérezBaroja explicó la función que cumplen el Colegio y la Asociación y la génesis del concurso y sus objetivos. Después hubo una conferencia divulgativa a cargo de José Luis García López, profesor de investigación del Centro de Investigaciones Biológicas (CSIC), sobre los antibióticos. A continuación, los alumnos premiados presentaron detalladamente su proyecto de investigación, con una brillantez y profundidad que sorprendió a los presentes, y cerró el acto la directora general de Educación Secundaria, Formación Profesional y Régimen Especial, Mª Luz Rodríguez de Llera Tejeda.
La experiencia ha sido lo suficientemente exitosa como para seguir adelante con ella. “La idea es que haya muchos más centros implicados y ayudar a implantar el trabajo con proyectos, cuya implantación aún es minoritaria. Por eso queremos colaborar con el profesorado para ponerles en contacto con instituciones de investigación para el desarrollo de los proyectos”, dice Emilio Gómez, que reconoce que la enseñanza actual aún es muy academicista y basada en contenidos más que en habilidades.
Además, no es lo mismo repetir experimentos bien probados, e incluso prepararlos para exhibirlos públicamente, como en las ferias de la ciencia; aquí se trata de un reto mucho mayor, por selec-


cionar una cuestión novedosa o su aplicación en un ámbito diferente al que se haya investigado ya, planteando todo su desarrollo, desde los antecedentes a la metodología y con una estructura formal tipo paper. Hace falta no solo que los y las estudiantes se vean capaces de afrontarlo sino también de contar con un profesorado dispuesto a guiarles y a aprovechar el enriquecimiento educativo que una tarea así puede proporcionar.
Para ampliar la masa crítica de participantes, Íñigo Pérez-Baroja anunció en el acto de entrega que “recogiendo el lema de ‘la suma de todos’ de la Comunidad de Madrid, el año próximo invitaremos a todos los centros, institutos y colegios, públicos, privados y concertados a participar en el concurso”. Aunque ello supondrá una acumulación de trabajo para los miembros del jurado, el Colegio y la Asociación pretenden con ello poner su grano de arena en el camino de la excelencia educativa en el alumnado que está justo en el escalón anterior a su entrada en la universidad, donde esta experiencia puede ayudarle a su desarrollo personal y formativo. Q
La industria Química es, sin duda, uno de los principales y más estratégicos sectores de la economía española. Desde el punto de vista puramente económico, la química es, tras el sector alimentario, el segundo sector industrial de la economía española, generando el 14,3 % del Producto Industrial Bruto, y una cifra de negocios que alcanzó en 2023 los 82.493 millones de euros. El sector ha acumulado un crecimiento del 42,1 % en el periodo 2015-2023, pese al ajuste de la demanda experimentado, que le llevó a retroceder un 8,2 %, por la negativa evolución de la inflación y el alto volumen de stocks acumulados debido a la pandemia y la posterior invasión de Ucrania. Esta cifra sitúa al sector químico como el segundo mayor de la economía española, solo por detrás de alimentación y bebidas. Es, además, el segundo sector en cuanto a exportaciones de la economía española, por detrás de la automoción.
La industria química, un sector sostenible, competitivo y resiliente
La industria química genera una importante actividad económica a través de su demanda de productos, tecnologías y servicios, tanto indirectos como inducidos, lo que supone el 6,1 % de la riqueza total generada por nuestro país.
En cuanto a las exportaciones, la industria química se sitúa como el segundo exportador de la economía española (por CNAE), por detrás de la automoción, llegando a 59.603 millones de euros. El ajuste experimentado en 2023 por la retracción de la demanda, después de incrementos muy importantes en los años 2021 y 2022, supuso un retroceso del 11 %. Sin embargo, la proyección internacional continúa siendo una de las principales bazas competitivas del sector químico. De hecho, el 72,3 % de su cifra de negocios la realiza ya fuera de España.
Aunque el mercado de la Unión Europea aglutina el 60 % de las ventas en el exterior, los países extracomunitarios registraron mayor relevancia, ocupando Suiza, Estados Unidos, China y el Reino Unido las posiciones 5ª, 8ª, 9ª y 10ª respectivamente, entre los principales destinos de las exportaciones.
Otro factor que muestra la resiliencia de esta industria frente a otras actividades es la madurez de sus empresas. Así, el 35,2 % de las 3.726 empresas del sector tienen una edad superior a 20 años, duplicando prácticamente la media de las empresas españolas.
Desde el punto de vista del empleo, el sector químico alcanzó los 233.000 asalariados directos, a los que se añaden otros 403.100 empleos indirectos y 156.100 inducidos, generando en total 800.000 empleos dependientes de su actividad, que suponen el 5,5 % de la población activa asalariada del sector privado de España.
Respecto a la estabilidad laboral, el sector químico supera ampliamente los registros de contratación indefinida de las distintas actividades económicas, alcanzando un 93,6 %. El salario medio por trabajador supera los 39.967 euros anuales, un 57 % más que el salario medio en España (25.353 €/año) y un 40 % más que la media industrial (28.483 €/año). Apuesta también por la alta cualificación de su capital humano, al destinar a formación una media de 183€ persona/año, muy por encima de la media industrial (110,5€/año) o la media nacional (68,3€/año).

Texto: Juan Labat, director general de Feique.

Asimismo, uno de los objetivos de la industria química española es incrementar la presencia de mujeres en los centros de trabajo. Así, el sector alcanzó su récord en términos de paridad y actualmente el 44,4 % del personal asalariado son mujeres (103.100), frente al 36,2 % de 2019. Si bien en los ámbitos técnicos, científicos, de administración o gestión, la progresión ha sido más eficaz, está siendo más complejo en las áreas relacionadas con la operación de planta, aunque también se aprecia la mejora.
Por otra parte, uno de los principales rasgos de este sector y clave de su competitividad radica en su capacidad innovadora. Con una inversión de 2.000 millones de euros, las empresas químicas lideraron la inversión en innovación en el conjunto de la industria española, aglutinando el 24 % del total, y con una inversión media anual por empresa que alcanza los 537.000 €. También encabeza la contratación de personal investigador y técnico dedicado a I+D+i. Así, la quinta parte del personal investigador contratado por la industria española ejerce su actividad en la industria química.
Esta apuesta por la innovación está plenamente vinculada con el compromiso del sector con la transición energética y la neutralidad climática. En el largo plazo, la industria química no solo pone el foco en ser competitiva sino también en ser plenamente sostenible, con el objetivo claro de alcanzar la descarbonización completa del sector antes de 2050. Y para ello se estima que, a nivel europeo, el sector requerirá de inversiones de un billón de euros hasta esa fecha.
Una cifra que llevará aparejada la modificación de las operaciones de suministro y que requerirá el desarrollo de procesos y tecnologías —alguna de ellas todavía desconocidas o incipientes— que permitan neutralizar sus emisiones de CO2.
La industria química abastece de productos y tecnologías al 98 % de los sectores productivos y se encuentra en la base de innumerables cadenas de producción. Por ello, desarrolla continuamente nuevos procesos que demanden un menor consumo energético por unidad de producción, así como avances tecnológicos que permitan mejorar la eficiencia de los existentes. Desde 2005, el consumo energético del sector se ha reducido un 42,4 %.
Uno de los objetivos prioritarios del sector químico es alcanzar la neutralidad climática, eliminando progresivamente tanto sus emisiones de proceso como las de combustión. En el caso de las primeras, la reducción registrada desde 2005 es del 41,9 %, si bien será preciso avanzar en la captura y almacenamiento de CO2 para alcanzar el objetivo.
Además de la eficiencia de los procesos, las tecnologías de captura del CO2 serán indispensables para alcanzar los objetivos de reducción de emisiones de gases de efecto invernadero. De hecho, la Comisión y el Parlamento Europeo han admitido que no será posible alcanzar los objetivos de neutralidad de emisiones en 2050 sin las tecnologías de captura, almacenamiento y uso del CO2 (CAUC). Éstas, no solo son la única alternativa tecnológica para retirar el CO2 de la atmósfera por vía directa o indirecta, sino también para
reducir emisiones en sectores con emisiones de proceso complejas de abatir o para proporcionar nuevas materias primas que no sean de origen fósil.
En este escenario, es importante remarcar también que el hidrógeno renovable va a jugar un protagonismo evidente y será una de las tecnologías más relevantes y que va a captar un mayor volumen de inversión en los próximos años como alternativa al gas. Al igual que otros gases renovables, el hidrógeno verde va a ayudar al sector químico a desfosilizar sus procesos de producción en su uso como materia prima y también como vector energético limpio que sustituirá progresivamente el uso de combustibles fósiles, ya sea para la producción de energía térmica, para ofrecer alternativas de movilidad o para sistemas de almacenamiento.
En cualquier caso, uno de los principales retos del hidrógeno verde es que todavía no es competitivo. Se necesitan precios eléctricos más reducidos, infraestructuras adecuadas con los más altos estándares de seguridad y una regulación específica y armonizada.
Por otra parte, el sector, más allá de su propio desempeño, va a jugar un papel fundamental para lograr los objetivos de descarbonización para 2050 marcados por el Green Deal, desarrollando tecnologías y procesos innovadores net-zero para otros sectores industriales.
Sin lugar a duda, el sector químico continúa demostrando ser más estratégico que nunca para garantizar el funcionamiento y desarrollo de nuestra sociedad actual y futura. Q
Poco a poco las baterías de litio han ido apareciendo en nuestras vidas con la demanda en auge del almacenamiento energético. Las hemos visto en, teléfonos móviles, patinetes, herramientas eléctricas, drones… y en vehículos eléctricos. La mayoría de ellas, y más concretamente las baterías de vehículos eléctricos, una vez que finalizan su ciclo de vida se incluyen en la cadena de reciclado y más concretamente en la valorización, cuya definición (según la Ley 7/2022, de 8 de abril, de Residuos y Suelos Contaminados para una Economía Circular) incluye cualquier operación cuyo resultado principal sea que el residuo sirva a una finalidad útil al sustituir a otros materiales, que de otro modo se habrían utilizado para cumplir una función particular, o que el residuo sea preparado para cumplir esa función en la instalación o en la economía en general.
Con el nuevo Reglamento (UE) 2023/1542 del Parlamento Europeo y del Consejo, de 12 de julio de 2023, relativo a Pilas, Baterías y sus Residuos, por el que se modifican la Directiva 2008/98/CE y el Reglamento (UE) 2019/1020 y se deroga la Directiva 2006/66/CE, en su Anexo XII a nivel europeo, se establecen varios objetivos tanto de reciclaje como de valorización y como de los niveles mínimos de materiales reciclados que deben contenerse en lo que respecta a las baterías industriales, de automoción y para vehículos eléctricos, estableciendo metas temporales. El propio Reglamento fija, para el año 2025, como objetivo alcanzar un 65 % de eficiencia de reciclado de pilas o baterías de litio y un 70 % para finales del 2030. En cuanto a los objetivos de valorización de materiales, establece para 2027 la recuperación de litio a partir de los residuos de pilas y baterías de litio en un 50 %, y un 80 % para finales de 2031.

Texto: Borja Álvarez Muñoz, CEO de Envirobat España S. L.
Según un Informe de Bloomberg New Finance, se espera que en 2040 se comercialicen 41,58 millones de vehículos eléctricos en todo el mundo (Electric Vehicle Outlook, 2017) y que el 60 % de ellos incorporen baterías de iones de litio[1].
En 2017, había 3 millones de vehículos eléctricos en el stock mundial, que se espera que crezca hasta 125 millones para 2030 y 530 millones para 2040[2]
Se prevé que China, el gigante asiático, a partir del 2025, necesitará unas 800.000
toneladas anuales de carbonato de litio para satisfacer la demanda creciente de vehículos eléctricos. Y se prevé un aumento de su capacidad de producción de baterías 8 veces superior para el 2027. Y es que para obtener de la extracción de mineral 1 tonelada de litio ion se necesitan 250 toneladas del mineral, o 750 toneladas de salmuera rica en litio [3] . Según indica la Asociación Española de Proveedores de Automoción (Sernauto) y a la vista de estos datos, se prevé que no habrá suficiente litio o cobalto. “Se ha estimado que Europa necesitará casi 60 veces más litio y 15 veces más cobalto de aquí al 2050 para los coches eléctricos y el almacenamiento de energía”[4] De acuerdo con el informe anual de noviembre del 2023 de Recyclia, entidad administradora de residuos eléctricos y electrónicos, pilas y luminarias usadas de nuestro país, las perspectivas sobre el despliegue de la movilidad eléctrica en España y la generación de residuos de baterías son las siguientes a grandes rasgos:
n La transición hacia una movilidad sostenible está en marcha: en 2022 se matricularon en España 340.000 vehículos eléctricos y el objetivo para 2030 es alcanzar los 5,5 millones de vehículos eléctricos.
n Para 2030, se estima que más de 100.000 baterías de vehículos eléctricos estarán utilizándose en segundas vidas y casi 20.000 podrían
reutilizarse de nuevo en vehículos eléctricos.
n Las baterías disponibles para ser tratadas en plantas de reciclaje en el año 2030 se prevé que ronden las 40.000.
Atendiendo a las demandas normativas y dentro de la mejora continua para el desarrollo de una economía circular más eficiente, los procesos de reciclaje que se desarrollan en Envirobat España SL y concretamente para las baterías de litio, guardan relación directa con la recuperación de los componentes de alto valor presentes en la Black Mass, con el objetivo principal de valorización de los componentes más escasos para ser reutilizados como materias primas secundarias en la cadena de valor de manufactura de nuevas baterías de litio. Para ello se desarrollan distintos procesos basados en:
n El pretratamiento mecánico de las celdas de litio
n Tratamiento hidrometalúrgico
Según los datos que están disponibles, hasta 2023 la tendencia del mercado es hacia un incremento de la demanda de cantidad de baterías que no contienen ni cadmio ni plomo, junto a un ligero incremento de las baterías que contienen cadmio y una estabilización de la demanda de las baterías de plomo (ver gráfico).
Estos datos hacen evidente la necesidad de, además de concienciar convenientemente a la población, desarrollar y mejorar los actuales procesos de reciclaje, sobre todo en lo referido no solo a la recuperación de metales valiosos críticos, sino también de elementos no metálicos (como pueden ser los del propio electrolito de la batería, que ahora mismo no se recupera). Por ello, la investigación asociada al reciclaje de baterías está trabajando en identificar nuevas técnicas de reciclaje o, en su caso, modelos y vías con las que impulsar y mejorar los procesos ya existentes y desarrollar métodos novedosos con un alto grado de recuperación, eficiencia e impacto nulo en emisiones y desechos. Envirobat es una empresa especializada en la gestión, tratamiento y aprovechamiento de los residuos de pilas y baterías, incluidas las de iones de litio en cualquiera de sus formas, como aquellas provenientes de vehículos eléctricos e híbridos al final de su primera vida útil. Nuestra actividad genera 25
Gráfico. Cantidad puesta en el mercado según su contenido.
puestos de trabajo estables e indefinidos, entre personal directivo, técnicos/as investigadores/as, administrativos/as, oficiales de primera y operarios/as especializados/as de planta. Aportamos una gestión necesaria y fundamental en la reducción de la huella de carbono en nuestro país, con la gestión de más del 60 % de la generación de esta fracción de residuos, el 40 % de Portugal y el 50 % de Italia; lo que nos posiciona como una pequeña empresa líder en el mercado de la península ibérica en la reducción de la contaminación medioambiental de estos residuos altamente peligrosos.
Además, somos una empresa con un programa propio de investigación en el área de recuperación de metales y el proceso de recuperación de, entre otros, el litio ion de las baterías utilizadas para movilidad. Nuestro conocimiento en los procesos de desensamblado y las investigaciones previas desarrolladas en esta área, nos convierten en una empresa única para la consecución de dos de los aspectos más relevantes de los desafíos planteados en la iniciativa España 2050: el primero “ser más productivos para crecer mejor”, y el cuarto “convertirnos en una sociedad neutra en carbono, sostenible y resiliente al cambio climático”.
Envirobat, en fiel cumplimiento del artículo 8.1 de la Ley 7/2022, de 8 de abril, de Residuos y Suelos Contaminados para una Economía Circular, aplica en todos los proyectos e iniciativas medioambientales la jerarquía de residuos de acuerdo en el orden de prioridad marcado por la legislación nacional y europea: la prevención, la preparación para la reutilización, el reciclado y como última opción la eliminación.
Envirobat cuenta desde el 2020 con la Autorización Ambiental R14, que permite realizar las operaciones de preparación para la reutilización en una segunda vida de los componentes recuperados de baterías desechadas (incluidas las de litio ion en cualquiera de sus formas). Basándonos en esto, estamos desarrollando diversos proyectos de desarrollo experimental y de innovación industrial con diferentes niveles de madurez tecnológica (TRL6 a TRL9), instalando una planta piloto avanzada de demostración industrial innovadora en la visión circular de las baterías desechadas, desde la recogida, desmantelamiento, desmontaje, recuperación de los componentes valiosos, testeo técnico de las celdas o módulos y segunda vida o reciclaje, llegando en estos momentos, a Eco-diseñar nuevos packs de baterías reutilizando en su segunda vida útil estas celdas recuperadas y garantizando la reducción del 80 % del impacto ambiental que puede llegar a tener durante todo su ciclo de vida.
En la sociedad hay una preocupación creciente por los problemas derivados del agotamiento de los recursos naturales y la degradación ambiental. A esta demanda social, desde las empresas respondemos ofreciendo productos "más verdes" y empleando procesos de producción "más limpios". Por esta razón, cada vez más las empresas llegamos a la conclusión de que merece la pena ir más allá del estricto cumplimiento legal, adoptar estrategias de prevención de la contaminación e implantar sistemas de gestión del ecodiseño para mejorar el desempeño ambiental de sus productos.
En 2023, Envirobat obtuvo una patente de invención propia (nº solicitud: P2021130945 / nº Publicación: ES2938647), sobre un nuevo proceso de aleación de aluminotermia (Al-Zn-Mn), a partir de la masa negra obtenida del proceso de tratamiento mecánico de los residuos de pilas alcalinas (empleando material anódico y catódico mezclado), con latas de aluminio procedentes de bebidas gaseosas desechadas. Conseguimos así patentar una aleación en aluminio con mayor resistencia, dureza y rendimiento que otras aleaciones que utilizan materiales de alta pureza y por separado (ánodo y cátodo). Esta invención está siendo utilizada actualmente en la fabricación de piezas en el sector de la automoción, demostrando una ventaja de rendimiento para este sector claramente apreciable a nivel industrial y comercial.
Además, ese mismo año se obtuvo la Autorización Ambiental R4, que permite realizar los procesos de tratamiento mecánico y fisicoquímico en laboratorio con tecnología hidrometalúrgica, para la obtención de fracciones destinadas al reciclado o valorizables sobre la masa negra de baterías de litio ion en cualquiera de sus formas. Actualmente, estamos desplegando proyectos de I+D sobre procesos de baterías circulares, con repercusiones medioambientales positivas, avanzando en la recuperación del litio y el cobalto, como metales y materiales valiosos presentes en esta masa negra tan escasos y necesarios en nuestro continente, para ser reutilizados como materia prima secundaria en la cadena de valor de la manufactura de nuevas baterías. Finalmente, el Know-how ad-
quirido gracias al desarrollo de estos proyectos es fundamental de cara a enfocar y abordar otras nuevas iniciativas de I+D. Gracias a los resultados obtenidos en el proyecto desarrollado se han planteado ya, y se están llevando a cabo, estudios preliminares para abordar el reciclado de otras fracciones presentes en las baterías de litio ion, como puede ser el níquel, manganeso y grafito, entre otros.
Debemos pasar del antiguo modelo económico lineal de globalización, absolutamente centralizado en unas pocas zonas geográficas, con una visión geopolítica y de energías de combustibles fósiles; a un mundo más distribuido, más localizado, de múltiples puntos circulares, que deberán estar distribuidos en diferentes puntos estratégicos del globo, mucho más cerca del usuario final, apostando por la incorporación de la innovación y la tecnología en la generación de riqueza, garantizando la fabricación más cercana al usuario final, y el suministro global de materias primas y reduciendo la dependencia a puntos concretos y localizados de generación.
Necesitamos redoblar los esfuerzos, tener mayor protagonismo desde la industria para poder revertir esta tendencia, porque el ecodiseño, la ecoinnovación y la ecoeficiencia tienen que jugar un rol fundamental en cómo debemos utilizar las materias primas y los residuos como recursos y enfrentar el desafío tremendo que tenemos todos por delante.
Envirobat concibe la economía circular como el único camino posible para conseguir una industria del almacenamiento energético competitiva y soste-

nible a medio y largo plazo. Por ello, considera imprescindible impulsar el desarrollo de modelos circulares y de proximidad en el sector, que favorezcan la reducción del impacto medioambiental a lo largo de las cadenas de valor y en todas las fases del ciclo de vida de las baterías.
En resumen, es el momento de demostrar alternativas rentables y modelos de negocio basados en conceptos de circularidad, que permitan ampliar radicalmente la vida útil de las baterías después de terminar su primera vida útil en el sector de los vehículos eléctricos, mediante su transformación en nuevos productos second life para aplicaciones energéticas diversas. Los conceptos avanzados de reciclaje son soluciones incuestionables que allanan el camino hacia usos más eficientes de las baterías, aumentando el flujo de materias primas, reduciendo el impacto medioambiental de su producción y recuperando materias primas críticas.
Notas
1Agencia Internacional de la Energía, Global EV Outlook 2018, 2018, http://www.iea.org, (consultado el 25/11/2018).
J. Lippert, Electric Vehicles, https:// www.bloomberg.com/quicktake/electricvehicles.
2https://computerhoy.com/noticias/motor/ triste-realidad-reciclaje-baterias-cocheselectricos-524851
3https://www.lavanguardia.com/motor/ actualidad/20210517/7456307/bateriacoche-electrico-fabricacion-reciclaje-problema-sostenibilidad.html
4https://www.lavanguardia.com/motor/ actualidad/20210517/7456307/bateriacoche-electrico-fabricacion-reciclaje-problema-sostenibilidad.html
Bibliografía adicional:
–I Informe anual de Recyclia, noviembre del 2020, Tendencias en la industria del reciclaje de RAEE y pilas en España.
–II Informe anual de Recyclia, noviembre del 2021, Tendencias en la industria del reciclaje de RAEE y pilas en España.
–III Informe anual de Recyclia, noviembre del 2022, Tendencias en la industria del reciclaje de RAEE y pilas en España.
–IV Informe anual de Recyclia, noviembre del 2023, Tendencias en la industria del reciclaje de RAEE y pilas en España.
–Presentación: “Conferencia Panorámica Internacional del Litio 2024” de Envirobat España SL.
Colegios oficiales la candidatura formada por:
Decano-presidente
Ricardo Díaz Martín Vicedecana 1ª
Elecciones 2024 y toma de posesión de la Junta Directiva del Colegio de Químicos de Madrid
El 19 de marzo de 2024 tuvo lugar la proclamación de la única candidatura para la Junta Directiva del Colegio de Químicos, que tomó posesión el día 4 de abril y que estaba constituida por los siguientes colegiados:
Presidente
Íñigo Pérez-Baroja Verde
Vicedecano 1º
Donato Herrera Muñoz
Vicedecano 2º
Tomás García Martín
Secretario
Ángel Prieto Maeso
Tesorera
María Esther Lindoso García
Vicesecretaria
Rosario García Giménez
Interventor
Miguel Ladero Galán
Vocales
María del Mar Alarcón Hernández
David Antonio Cáceres Monllor
María del Carmen Clemente Jul
María Dueñas Pérez
Esther Gómez Mejía
José Manuel González Estévez
Antonio Gutiérrez Maroto
Vocales delegados
Puertollano: María del Carmen Sánchez
Hipólito
Castilla y León: Jesús Pérez Cabello
Elecciones del Consejo General de Colegios de Químicos de España
El 12 de enero de 2024 se celebró la Asamblea General del Consejo General de Colegios de Químicos de España y fue elegida por mayoría absoluta del conjunto de
Ana Elduque Palomo Vicedecana 2ª
Fuensanta Máximo González García
Secretario general
Juan Antonio Revenga
Tesorera
Lucía Grijalbo Fernández.
Desde estas páginas felicitamos a los miembros de dicha candidatura, en especial a nuestros tres compañeros de Madrid, Ricardo Díaz Martín, Juan Antonio Revenga y Lucía Grijalbo Fernández.
Premios Suschem a Jóvenes
Investigadores Químicos 2023 y convocatoria 2024
La Plataforma Tecnológica y de Innovación de Química Sostenible SusChem España entregó el pasado año los premios SusChem a Jóvenes Investigadores Químicos 2023, su 15ª edición, a Francisco Javier Sánchez Baygual, en la categoría Futura; a Pablo Garrido Barros, en la Categoría Investiga; y a Marta Mon Conejero, en la Categoría Innova.
IN MEMORIAM
Isabel Mijares García-Pelayo
LAdemás, SusChem-España, convoca la XVI Edición de sus premios destinados a reconocer e impulsar la actividad científica y divulgativa de los jóvenes investigadores que desarrollan su labor en las diferentes áreas de la química y disciplinas afines.
Día Mundial de la Seguridad y Salud en el Trabajo 2024
El 17 de Mayo tuvo lugar el Día Mundial de la Seguridad y Salud en el Trabajo en el Auditorio Pedro Almodóvar de Puertollano. Durante el acto se impartieron las conferencias:
n “Gestión del Riesgo Químico en Evolución: El Camino hacia un Futuro más seguro”, impartida por Andrés Ortega Fosch– director nacional de Prevor España. n “Estrés: Retrato del mayor asesino de nuestro tiempo”, impartida por Tomás García Castro, capitán de la Guardia Civil, y responsable de Prevención de Riesgos Laborales de la Comandancia de Murcia. Así mismo, se hizo entrega de los XIII Premios Clodoaldo Jiménez Izquierdo, de la Asociación Regional de Químicos y Profesionales de la Industria de Castilla la Mancha (ARQUICMA), y los premios del

a química extremeña María Isabel Mijares García-Pelayo falleció en Madrid el pasado mes de febrero. Nacida en Mérida en 1942, estudió Química en la Universidad Complutense de Madrid y se licenció en Enología y Degustación de Vinos por la Universidad de Burdeos. Considerada la primera enóloga en España, en 1982 se convirtió en la primera mujer en presidir un Consejo Regulador del Vino, la Denominación de Origen Valdepeñas (Ciudad Real). También fue la primera en estar al frente de una bodega, Palacio de Arganza, en Villafranca del Bierzo (León).
Su extenso currículum también incluye el cargo de jefa de proyectos en Naciones Unidas, para el asesoramiento sobre prácticas vitivinícolas a los gobiernos, la Secretaría General de la Unión Internacional de Enólogos y su nombramiento como académica de la Real Academia de Gastronomía.
Publicó varios libros y numerosos artículos en revistas especializadas, destacando su participación en la Guía Repsol de vinos, a cargo del Equipo Team, referencia en el sector. Obtuvo muchos premios y reconocimientos, entre ellos el de Colegiada Distinguida del Ilustre Colegio Oficial de Químicos de Madrid, y la Insignia de Oro y Brillantes de la Asociación de Químicos e Ingenieros Químicos de Madrid, en 2015
De carácter extrovertido y alegre, siempre respondía generosamente y con cariño a cualquiera que se acercara a ella. El mundo de la enología pierde a su gran divulgadora. Por eso, desde estas páginas queremos rendir homenaje y expresar nuestro inolvidable recuerdo hacia tan ilustre compañera. Descanse en paz la gran señora del vino. Q
El Colegio y la Asociación de Químicos e Ingenieros Químicos de Madrid celebraron las siguientes conferencias:
Actualización normativa cosmética 2022-23 n 14 de noviembre de 2022
Organizada por la Sociedad Española de Químicos Cosméticos
Ponente:
José Vicente Calomarde Burgaleta
Mesa Redonda: El Litio elemento estratégico en la actualidad n 16 de noviembre de 2023
Organizada por la Sección Técnica de Ingeniería Química, Geoquimica, Prevención de Riesgos Laborales y Medio Ambiente.
Ponentes:
n Jesús Rincón, profesor de Investigación del CSIC y Científico Col. Honorífico de la UMH-Elche.
n Pío Callejas, Científico Col. Honorífico de la UMH-Elche
n David Ruiz de León, especialista en riesgos RBQ. Jefe de Grupo del Cuerpo de Bomberos del Ayuntamiento de Madrid
n Micheel Acosta, jefe de Proyectos de Envirobat
Moderadora:
CGRICT a diversas instituciones y personalidades.
Guadalupe Ortiz de Landázuri candidata a patrona de los químicos de Madrid
El 9 de mayo de 2024 el Ilustre Colegio Oficial de Químicos de Madrid presentó a su candidata a nueva patrona, la Beata Guadalupe Ortiz de Landázuri Fernández de Heredia, doctora en Ciencias Químicas por la Universidad Complutense de Madrid y catedrática del I.E.S. Santa Engracia de la Comunidad de Madrid. Su vocación docente, su fe y su dedicación a los demás, la convierten en una referente de la dimensión ética y social de su labor. La beata, que está en proceso de canonización, se une así a San Alberto Magno, patrón de las ciencias, como intercesora de esta organización colegiada. El acto académico, que contó con numerosos asistentes, tuvo lugar en la sede del Colegio de Químicos de Madrid, y fue
n Mª del Carmen Clemente Jul, catedrática Emérita de la UPM. Presidenta de la Sección Técnica de Ingeniería Química.
Panorámica internacional del litio
n 25 de enero de 2024 Organizada por la Sección Técnica de Ingeniería Química
Ponentes:
n Javier García Guinea, profesor de investigación del Departamento de Geología del MNCN, CSIC, España.
n Joao Labrincha, catedrático de la Universidad de Abreiro, Portugal. n Fabrizio Ruiz y Fabiana Gennari, investigadores de CNEA y CONICET, Argentina.
n Borja Alvarez, Envirobat, España.
Presentadora:
n Mª del Carmen Clemente Jul.
Coordinador:
n Jesús María Rincón López, profesor de investigación del CSIC y Científico Col. Honorífico de la UMH-Elche.
Moderador:
n José Querol San Juan, doctor en Ciencias Químicas, secretario de la Sección Técnica de Ingeniería Química.
Ingeniería del cuerpo humano n 15 de febrero de 2024

presidido por su decano, Iñigo Pérez-Baroja Verde, y el postulador diocesano de la causa, José Carlos Martín de la Hoz. En el evento, que contó con gran número de asistentes, comunicaron la decisión de nombrar patrona a esta laica madrileña que está en proceso de canonización. Con este motivo, el 18 de mayo tuvo lugar la celebración de una misa en el Real Oratorio de Caballero de Gracia en Madrid. La ceremonia conmemoró el quinto aniversario de su beatificación, el 18 de mayo
Organizada por la Sección Técnica de Ingeniería Química
Ponente:
n Profesor doctor José Ramon Álvarez
Collado
Presentadora:
n Mª del Carmen Clemente Jul.
Moderador:
n José Querol San Juan.
Celebradas en otras sedes De la pizarra al hidrógeno, ocho décadas del complejo n 17 noviembre de 2023
Museo Municipal Cristina García Rodero de Puertollano
Ponente:
n Alejandro Llanos, doctor en CC. Químicas.
Corrección Enlace 47
En el número anterior de nuestra revista, en la información sobre la Mesa Redonda: Desde el vidrio natural a las vidrieras, celebrada el 17 noviembre de 2022 y organizada por la Sección Técnica de Ingeniería Química con motivo de los actos de celebración de la festividad de San Alberto Magno, se omitió que dicha mesa fue coordinada y moderada por el doctor Jesús María Rincón López.
de 2019, y marcó su reciente nombramiento como patrona del Colegio. Guadalupe Ortiz de Landázuri (Madrid, 1916), una de las primeras mujeres que estudió química en España y una de las primeras mujeres del Opus Dei. Dedicó gran parte de su vida laboral a la docencia como profesora de química, destacando en su generosa entrega y dedicación a sus alumnos. Como investigadora, colaboró con el Consejo Superior de Investigaciones Científicas. Promovió obras sociales y de formación de la mujer en muchos lugares de España, especialmente en Madrid, y sobre todo en México y Guatemala. Falleció en 1975 en la Clínica Universidad de Navarra, por un problema cardíaco.
María del Carmen Clemente Jul, nueva académica de número de la Real Academia de Doctores de España En una solemne ceremonia celebrada el pasado 17 de abril, nuestra compañera Ma-
ría del Carmen Clemente Jul fue oficialmente investida como académica de número de la Real Academia de Doctores de España, con la medalla número 5 y adscrita a la Sección de Ciencias Experimentales. Carmen pronunció un discurso magistral sobre el tema fundamental de la energía del futuro y ofreció una reflexión profunda sobre los desafíos y oportunidades que enfrenta la sociedad en este ámbito crucial.
La nueva académica recibió el elogio y reconocimiento de sus colegas, incluida la respuesta de la Dra. Beatriz Yolanda Moratilla Soria, académica de número de la Sección de Ingeniería, que realizó su presentación. Este intercambio intelectual subrayó la importancia de la colaboración y el intercambio de ideas en la Academia. El reconocimiento no solo representa un hito personal en la carrera

académica de Maria del Carmen Clemente, sino que también enriquece el cuerpo de conocimiento y experiencia de la Real Academia de Doctores de España, fortaleciendo su compromiso con la excelen-
Acuerdos
Convenios de colaboración firmados por el Colegio, además de los existentes de años anteriores:
Fundación Orquesta y Coro de la Comunidad de Madrid
En octubre el Colegio firmó un acuerdo marco con la Fundación Orcam, que gestiona la Orquesta y Coro de la Comunidad de Madrid, la Joven Orquesta de la Comunidad de Madrid (Jorcam) y otras formaciones musicales, por el que los colegiados se benefician de un descuento del 15 % en abonos y entradas a los conciertos (sin incluir los gastos de gestión) durante las temporadas 2023-2024 y 2024-2025. Dicho descuento será del 20 % para grupos superiores a 20 personas.
Agencia de Marketing
La agencia de marketing y el Colegio de Químicos de Madrid firmaron un acuerdo de colaboración por el que dicha Agencia ofrecerá la prestación
cia académica y el avance del conocimiento en nuestro país.
Desde estas páginas damos la enhorabuena y felicitamos a nuestra compañera por tan merecido y distinguido nombramiento
Relaciones con las Instituciones Públicas
Con el fin de defender y ordenar la profesión de Químicos, el Colegio Oficial de Químicos de Madrid ha mantenido reuniones muy positivas con las siguientes administraciones públicas:
◼ Consejería Economía, Hacienda y Empleo de la Comunidad Madrid
◼ Consejería Educación, Ciencia y Universidades de la Comunidad Madrid
◼ Consejería Vivienda, transportes e Infraestructuras
◼ Consejería Medio Ambiente, Agricultura e Interior
◼ Consejería Familia, Juventud y Asuntos sociales,
◼ Consejería de Agricultura, Ganadería y desarrollo rural de la Junta de Comunidades de Castilla la Mancha
◼ Consejería de desarrollo sostenible de la Junta de Comunidades de Castilla la Mancha
◼ Ayuntamiento de Madrid
De este modo se establecen sinergias para compartir conocimientos e intercambiar información, así como potenciar la formación continuada de los colegiados.
de servicios de diseño web y branding a los colegiados.
Mapfre
Con el objetivo de poner a disposición de los profesionales liberales las soluciones más novedosas, Mapfre ha lanzado al mercado su primer Plan de Pensiones de Empleo Simplificado para Autónomos.
Colegio San Alberto Magno de Madrid
La Asociación firmó un acuerdo de colaboración con el Colegio San Alberto Magno, cooperativa de profesores/as de enseñanza laica concertada desde Infantil hasta Bachillerato, para definir sinergias mutuas en materia de formación, descuentos, publicidad, asesoramiento etc.
Generaluz
El Colegio y Generaluz, empresa especializada en energía fotovoltaica, han acordado fomentar la investigación y
Intervenciones en centros de enseñanza
El Colegio de químicos impartió las siguientes charlas y talleres en centros educativos de la Comunidad de Madrid, para fomentar el aprendizaje, divulgar nuestra ciencia y orientar la vocación profesional de los jóvenes hacia la química:

◼ Colegio Villarkor (Alcorcón)
Alumnos: 3º ESO (1 grupo)
Ponente: Donato Herrera
◼ Colegio Beata Filipina (Madrid) Alumnos: 3º y 4º ESO (3 grupos en total)
Ponentes: Donato Herrera, Laura Pedrera y Sandra Rodríguez
◼ IES Europa (Móstoles)
Alumnos: 2º bachillerato (1 grupo)
Ponente: Esther Gómez
◼ Instituto Cardenal Cisneros. Madrid Alumnos: 2º de Bachillerato.
Título de la ponencia: El mundo de la Química y dónde trabaja un químico
Ponente: José Manuel González Estévez Q
elevar la conciencia sobre la importancia de las energías renovables para conseguir una sociedad más sostenible y consciente del medio ambiente. Nuestros colegiados podrán adquirir una placa solar de forma gratuita al contratar los servicios de Generaluz, tanto de forma particular como para sus empresas, con ventajas económicas.
Universidad CEU San Pablo
La Universidad CEU San Pablo ofrece una tarifa especial para colegiados y la posibilidad de obtener media beca en la realización del Curso “Experto en la Evaluación de la Seguridad y Expediente de Información del Producto Cosmético”.
Oferta de KTUIN
La empresa KTUIN, el mayor distribuidor oficial de Apple en España, ofrece descuentos especiales en sus productos a nuestros colegiados.
Mas información en la página web http://www.quimicosmadrid.org
La inauguración el pasado mes de abril del nuevo Centro Médico Juan Bravo, ubicado en la calle Juan Bravo número 10, mejora la oferta sanitaria de Nueva Mutua en la zona, junto al ya existente en la calle Claudio Coello 117. El nuevo centro cuenta con instalaciones modernas y espaciosas para garantizar a los pacientes una experiencia cómoda, segura y excelente desde el punto de vista clínico y de calidad asistencial.
Más especialidades, citas más próximas, mejor servicio
Este nuevo centro, gestionado por Nueva Mutua Sanitaria, ofrece una amplia gama de servicios médicos que incluyen el radiodiagnóstico con ecografía y eco-doppler, así como consultas de medicina general, aparato digestivo, ginecología y reumatología.
Estas especialidades se unen y complementan a las ofertadas en el Centro Médico Claudio Coello: laboratorio de análisis clínicos, medicina general y pediatría, medicina interna,

traumatología, fisioterapia y rehabilitación, podología y psicología.
Esta ampliación de las instalaciones ha permitido, además, extender y redistribuir las horas de consulta para acortar los plazos de las citas.
Comprometidos con su salud
Con esta nueva apertura, Nueva Mutua Sanitaria reafirma su compromiso con la excelencia en la atención médica, ofreciendo una red de centros mo-
dernos y especializados, diseñados para satisfacer las necesidades de salud de sus mutualistas.
Para solicitar cita previa puede acudir a la página web www.tecnosaludybienestar.com o bien contactar mediante los siguientes números de teléfono:
n Centro Médico Claudio Coello: 91 290 80 79
n Centro Médico Juan Bravo: 91 290 80 80

Festividad de San Alberto 2023
En noviembre de 2023, un año más, se celebró la festividad de San Alberto, Patrón de los químicos. Entre los actos organizados destacan:
n El día14 de Noviembre tuvo lugar la conferencia “Actualización de la normativa cosmética” organizada por la Sociedad Española de Químicos Cosméticos (SEQC) e impartida por José Vicente Calomarde. Consultor-gerente en Consultoría Industrial Cosmética
n El día 16 de noviembre tuvo lugar la mesa redonda “El litio, elemento estratégico en la actualidad”, organizada por la Sección Técnica de Ingeniería Química y en la que intervinieron como ponentes Jesús Rincón, profesor de investigación del CSIC y Científico Col. Honorífico de la UMH-Elche; Pío Callejas, Científico Col. Honorífico de la UMH-Elche; David Ruiz de León, especialista en Riesgos RBQ y jefe de grupo del Cuerpo de Bomberos del Ayuntamiento de Madrid; y Micheel Acosta, jefe de Proyectos de Envirobat. Como moderadora actuó Mª del Carmen Clemente, catedrática emérita de la UPM y presidenta de la Sección Técnica de Ingeniería Química.
n El día 17 de noviembre tuvo lugar en el Salón de actos del Museo Municipal Cristina Garcia Rodero de Puertollano la conferencia “De la pizarra al hidrógeno, ocho décadas del complejo”, organizada por la Delegación de Puertollano/ARQUICMA, cuyo ponente fue Alejandro Llanos, doctor en Ciencias Químicas.
Para finalizar la celebración de los actos en honor de nuestro patrón tuvo lugar una comida de confraternidad el día 25 de noviembre con la entrega de las siguientes distinciones:
Por parte del Colegio fue declarada “Colegiada Distinguida” Juana Bellanato Fontecha, por su labor en favor de la institución y en reconocimiento a sus méritos profesionales a lo largo de su dilatada vida laboral.
Asimismo, fueron nombrados “Colegiados Honorarios”: José María Martín Corrochano, oficial del Ejército de Tierra, caballero paracaidista y comandante del Cuartel General, Unidad Militar de Emergencias (UME), por su amplia trayectoria laboral en favor de la sociedad y su aportación en la defensa y divulgación de la química; y la empresa: Chemtrol, Proyectos y Sistemas S.L. (CHEPRO), por su apoyo hacia nuestra Institución a través del visado de proyectos, así como contratación y formación a colegiados para desarrollar su actividad.
Por su parte, la Asociación otorgó su máximo galardón, la insignia de oro y brillante a Emilio Gómez Castro, en reconocimiento a sus méritos profesionales y al trabajo realizado en nuestras Instituciones a lo largo de los años. Continuando con la tradición, en Honor a nuestro Santo Patrón, el día 18 de noviembre tuvo lugar la eucaristía por nuestros compañeros fallecidos, en la Parroquia San Juan Bosco, Colegio Salesiano finalizando la celebración de los actos de San Alberto 2022 con un aperitivo en los salones de la mencionada Parroquia.
San Alberto 2024. Como en años anteriores anunciamos desde estas líneas de Enlace 48 que se está trabajando en la organización de la celebración de San Alberto 2024, que tendrá lugar en el mes de noviembre y de la que informaremos extensamente en nuestro próximo número. Q
El Colegio Oficial de Químicos y Asociación de Químicos e Ingenieros Químicos de Madrid va a preparar durante el año 2024 la próxima convocatoria de oposiciones, para optar a la Escala de Técnicos Facultativos Superiores (A1) y Grado Medio (A2) de Organismos Autónomos del Ministerio de Medio Ambiente por el sistema general de acceso libre y promoción interna. Especialidad de Planificación y Gestión del Dominio Público.
Más Info: Ilustre Colegio Oficial y Asociación de Químicos e Ingenieros Químicos de Madrid C/ Lagasca n° 27 - 1° E - 28001 Madrid www.quimicosmadrid.org colquim@quimicosmadrid.org




Textos: Juan Quinto
El señuelo químico de los espermatozoides
Una de las carreras más espectaculares de la biología es la que protagonizan los espermatozoides en su pretensión de llegar al óvulo y fecundarlo. La competición es feroz, porque solo uno de ellos conseguirá el objetivo, Hace años que se sabe que en la búsqueda del objetivo se guían por estímulos químicos, moléculas que desprende el óvulo y que ellos detectan como si poseyeran, de alguna manera, un sentido del olfato específico. Ahora, científicos de la Universidad de Estocolmo han desvelado el papel que en este proceso juega una proteína, denominada SLC9C1, que se encuentra en la membrana de los espermatozoides y que interactúa con las señales químicas del óvulo desencadenando, como si fuera un toque de silbato, el arranque de la carrera. Lo que provoca el contacto es el intercambio de protones del interior celular por iones de sodio del exterior, lo que produce un incremento de la tensión eléctrica, que es lo que moviliza al espermatozoide. Además

del conocimiento sobre el proceso reproductivo que aporta la investigación, el hallazgo también puede tener aplicaciones prácticas, como “el desarrollo de nuevos anticonceptivos masculinos, que actúen bloqueando esta proteína", en palabras de David Drew, uno de los coautores del trabajo, que se ha publicado en Nature Q
Una batería que funciona con hemoglobina
La hemoglobina es una proteína que tiene una gran afinidad por el oxígeno. Por ello, está presente de forma masiva en los glóbulos rojos de la sangre para realizar su tarea de transportar oxígeno desde los pulmones a todos los tejidos del organismo y para recoger después el dióxido de carbono en el viaje de vuelta. Un equipo del Instituto Químico de Energía y Medio Ambiente de la Universidad de Córdoba pensó que esta afinidad de la hemoglobina podía ser aprovechada para crear una batería en la que facilitara las reacciones electroquímicas, en concreto baterías de zinc-aire. Y han hecho realidad su idea.
Se llena el primer hueco de la tabla periódica
Junto con un equipo de la Universidad Politécnica de Cartagena, y tras un estudio de la Universidad de Oxford, han demostrado que la hemoglobina presenta propiedades prometedoras como catalizador para el proceso de reducción y oxidación (redox) mediante el cual se genera energía en este tipo de sistemas. Se trata de una batería biocompatible, por lo que podría usarse en aparatos implantados, como los marcapasos, donde esta proteína se encarga de facilitar la reacción electroquímica llamada reacción de reducción de oxígeno (ORR). Según uno de los investigadores, Manuel Cano Luna, "el catalizador debe tener dos propiedades: absorber rápidamente moléculas de oxígeno y formar moléculas de

agua con relativa facilidad. Y la hemoglobina cumple estos requisitos". De hecho, el equipo consiguió que su prototipo de batería biocompatible funcionara con 0,165 miligramos de hemoglobina durante entre 20 y 30 días. Q

En 1869 Mendeléiev presentó su modelo de tabla periódica de los elementos dejando tres huecos en ella, asegurando que eran elementos que existían, aunque no se hubiesen descubierto aún y prediciendo sus características. Los denominó eka-boro, eka-aluminio y eka-silicio, porque estaban situados justamente debajo de esos elementos. Apenas cinco años después, su profecía quedó confirmada cuando se descubrió el segundo de ellos. En 1874 el químico francés Paul-Émile Lecoq de Boisbaudran estaba analizando espectroscópicamente una muestra de mineral de zinc y descubrió unas líneas espectrales desconocidas. Consiguió aislar el elemento que las producía y describió sus características, que coincidían con las previstas por Mendeléiev para el eka-aluminio. Lo llamó galio, por el nombre que los romanos habían dado al territorio de su país, Francia. Este descubrimiento confirmó la supremacía de la tabla de Mendeléiev sobre los modelos elaborados por otros químicos de la época.Q

La vida en directo
L a Sociedad Española de Ornitología, asociada a la internacional BirdLife, (SEO/Birdlife), es la decana de las organizaciones de defensa ambiental en España y en su actividad combina investigación, protección, divulgación y defensa de las aves, que son su centro de atención. Hace ya tiempo que inició una actividad de colocación de cámaras en directo, situadas en determinadas localizaciones estratégicas, que permiten seguir de forma permanente la actividad de algunas especies, como el buitre negro, el cernícalo primilla, el halcón peregrino y la cigüeña blanca, y algunos de los espacios más emble-
Vivir sin huella
Ana de Santos Gilsanz
Editorial Zenith. Grupo Planeta Barcelona, 2023 222 páginas. 18 euros.
Dmáticos de la naturaleza española, como el Parque Nacional de Doñana. Además de satisfacer la curiosidad de los aficionados a la contemplación de aves, SEO/Birdlife invita a quien lo desee a participar en la recogida de datos sobre “el comportamiento reproductivo de las especies (tiempo de incubación, número de huevos, número y tamaño de las presas, frecuencia de alimentación, tiempo de desarrollo de los pollos…)”, mediante la vigilancia a través de estas cámaras. Un buen ejemplo de lo que se conoce como ciencia ciudadana..

Un rincón para la química Museo de la Ciencia de Valladolid Avenida de Salamanca 59. 47014-Valladolid.
https://seo.org/camaras/

eterminar los efectos ambientales de nuestras actividades cotidianas y de los productos que consumimos es más sencillo utilizando esa herramienta desarrollada en los últimos años denominada huella ambiental. La autora de este libro, veterana periodista (y activista) de temas ambientales nos explica aquí el concepto de huella ambiental y ecológica, las diferentes huellas que lo conforman (la hídrica, la de carbono, la de plástico...), cómo se calcula y su importancia. Pero su obra no es un mero ejercicio descriptivo; es, sobre todo, un llamamiento para que el lector se comprometa a cambiar su comportamiento para eliminar, reducir o compensar su propia huella. Y para ello proporciona las recetas que permiten hacer ese cambio de la forma más asequible y aceptable. La idea que la mueve es la conciencia de que vivimos en un creciente déficit ecológico e hipotecando los recursos naturales que deberían poder disfrutar las futuras generaciones. Q7÷
El Museo de la Ciencia de Valladolid inauguró en 2011, el Año Internacional de la Química, un rincón de su exposición permanente dedicado a esta disciplina con el nombre de “La química a escena”, que ocupa más de 150 metros cuadrados. Un expositor muestra materiales que representan a algunos elementos, se puede jugar con una pantalla interactiva y hay paneles con diferentes propiedades de algunos elementos, como la fotoluminiscencia. Pero el elemento principal de la sala es una gran tabla periódica tridimensional y un panel dedicado a su creador, el ruso Mendeléiev. Está formada por 90 casillas (con forma de cubo y de 40 cm de lado), cada una representando a un elemento, aunque los lantánidos y actínidos solo están representados por su primer elemento. En el interior de los cubos hay objetos relacionados con el elemento correspondiente. En la parte superior hay una pantalla donde se ofrecen explicaciones de algunos elementos mediante materiales representativos, situados en un mostrador adyacente. Basta tocar un objeto para que en la pantalla se inicie el audiovisual. El espacio se completa con otros paneles y pantallas, una de ellas con una tabla periódica interactiva. Q
El estudio de los materiales de una pintura proporciona una información valiosa para conocer los procedimientos seguidos por los artistas, la época o el entorno geográfico en el que una obra se pudo realizar, así como para comprender mejor los procesos de fabricación de los materiales artísticos que se han utilizado en los diferentes períodos de la historia. De ahí la gran importancia que tiene la ciencia como soporte para el conocimiento de los materiales que forman parte de una obra de arte. Uno de los temas de estudio que, desde hace décadas, viene siendo de mucho interés es el análisis de los materiales utilizados para preparar los soportes de las pinturas, como trabajo previo a la creación artística. Estos ingredientes han sido tradicionalmente de origen local y, gracias a ello, pueden ofrecer una información significativa sobre el lugar de ejecución de una pintura y es, por tanto muy importante su estudio y conocimiento.
La preparación del soporte de una pintura es una labor esencialmente práctica y consiste en la aplicación de capas de espesor y composición variables: primero se extiende un aparejo que reduce la porosidad y las irregularidades del soporte y, a continuación, una imprimación que proporciona una superficie adecuada para empezar a pintar.
A mediados del siglo XVI comienza a utilizarse la pintura sobre lienzo en España y la incorporación de este nuevo soporte llevó asociado también otros procedimientos para su preparación, ya que el sistema utilizado para las tablas (superposición de gruesas capas de yeso), resultaba demasiado rígido para un material flexible y deformable como es la tela.
Los años finales del siglo XVI representan una transición hacia el uso pleno del lienzo, que sustituirá casi por completo a la tabla a lo largo del siglo XVII. En obras de este momento se encuentran varias opciones para la elección del aparejo y la imprimación, aunque la tendencia general va dirigida a la paulatina disminución del aparejo de yeso, hasta su práctica desaparición, en favor de una imprimación al óleo cada vez más gruesa y coloreada.

Texto: María Dolores Gayo. Licenciada en Ciencias Químicas. Documentación Técnica y Laboratorio. Área de Restauración. Museo Nacional del Prado Cenizas de madera lavadas de color grisáceo.
A comienzos del siglo XVII, como recoge Francisco Pacheco en su tratado Arte de la pintura, obra póstuma publicada en 1649, coexisten distintos métodos de aparejar los lienzos en España. Se utiliza la gacha de harina, la cola de origen animal - cola de guantes– y un tercer sistema que consiste en aplicar primero una mano de cola animal y después otra de yeso y cola; este último se ha encontrado en pocas ocasiones y siempre en obras del primer cuarto de siglo.
Además de estos materiales, encontrados a menudo en las pinturas, Pacheco hace mención a un cuarto tipo de aparejo: cola de guantes y ceniza cernida, con la información específica de “esto usan en Madrid”. Con mucha frecuencia, en los estudios llevados a cabo por algunos investigadores en ciertas pinturas del siglo XVII, se ha descrito un aparejo de color grisáceo que contiene, invariablemente, carbonato cálcico, partículas de negro carbón y una pequeña proporción de silicatos como componentes principales. En 2014 el Laboratorio del Museo del Prado publicó un trabajo con los resultados de los análisis realizados a fondo a este material, elaborando incluso distintas probetas según las instrucciones proporcionadas por Pacheco en su tratado, que permitieron la identificación de cenizas de madera lavadas en los aparejos de las obras pintadas en Madrid a lo largo del siglo XVII. En 2018, esta información pudo ser complementada por investigadores del Laboratorio del Metropolitan Museum de Nueva York, que dieron un paso importante en la caracterización de este tipo de aparejo, aportando cuantiosos datos de la composición de las cenizas desde el punto de vista mineralógico. En líneas generales, se trata de un material en el que el componente principal es la calcita, que presenta

una morfología característica que puede ser claramente observada mediante microscopía electrónica de barrido: partículas de gran tamaño, con forma poliédrica y superficie granulada; la abundante presencia de calcita en las cenizas se debe a la descomposición térmica de los oxalatos de calcio intra y extracelulares que tienen la mayoría de las plantas. Las cenizas contienen, además, pequeñas proporciones de silicatos y aluminosilicatos, partículas negras y otros compuestos de azufre, fósforo y potasio, todos ellos procedentes de los tejidos vegetales.
La ceniza de madera y la manufactura de la lejía
La ceniza obtenida de la madera quemada se empleaba para la obtención de la lejía mediante el lavado con agua caliente y posterior colado en el cernadero (lienzo grueso): el residuo que quedaba después de este proceso es el material que se reciclaba para aparejar los lienzos en Madrid, el aparejo de cernada según la denominación utilizada por Antonio Palomino en el Tomo II: La práctica de la pintura de su tratado publicado en 1715-24.
La palabra cernada ya no se utiliza en el español de hoy en día, pero sí aparece recogida en el diccionario de la lengua española con el siguiente significado: parte no disuelta de la ceniza que queda en el cernadero después de echada la lejía sobre la ropa. El proceso de hacer lejía para blanquear la ropa ha sido una práctica tradicional en toda Europa desde la antigüedad y en España se ha estado utilizando en zonas rurales hasta los años 50. El procedimiento consiste, esencialmente, en lavar las cenizas con agua caliente para así disolver

las sales presentes, principalmente las de potasio, obteniéndose una disolución fuertemente alcalina, la lejía, que se utiliza para blanquear la ropa. La ceniza

lavada era un material inerte, barato y accesible para los pintores e imprimadores profesionales que fácilmente podían reciclar y utilizar para aparejar los lienzos.
La cernada en los aparejos de las pinturas madrileñas del siglo XVII El aparejo de cernada se ha identificado principalmente en las pinturas realizadas en Madrid. Ya se utilizaba en la corte cuando Velázquez llega en 1623 y es el material presente aproximadamente en la mitad de los cuarenta cuadros de los que se tiene noticia, pintados por el artista en esta ciudad. Entre los pintores que trabajaron de forma temporal en Madrid se puede citar a Rubens,
quien, en su segundo viaje a España en 1628-29, pinta Adán y Eva (P-1692) sobre un lienzo con aparejo de cenizas, y también a Luca Giordano que lo utiliza en varias de sus obras de la década de 1690. El empleo de la cernada permanece en Madrid en las obras de los artistas como, por ejemplo, José Antolínez en su Retrato de niña (P-1227) pintado en 1660 y continua hasta finales del siglo, pero su uso va decreciendo en el siglo XVIII y solo algunos artistas utilizan este aparejo de forma excepcional. Si tenemos en cuenta que la cernada era un material abundante y fácilmente disponible, es lógico pensar que haya podido ser empleada también en otros lugares de España y así se ha podido comprobar, por ejemplo, en algunas pinturas sobre lienzo realizadas en Toledo por Fray Juan Bautista Maíno entre 1612 y 1624.
Bibliografía
—Maite Jover de Celis y María Dolores Gayo, “This they use in Madrid: the ground layer in paintings on canvas in 17th-century”, en Hèléne Dubois et al. (eds.), Making, and Transforming Art. Technology and Interpretation. Londres 2014, pp. 40-46.
—Federico Carò, Silvia Centeno y Dorothy Mahon, “Painting with recycled materials: on the morphology of calcite pseudomorphs as evidence of the use of wood ash residues in Baroque paintings”, HeritageScience, 6, 3 (2018), —https://heritagesciencejournal. springeropen.com/ articles/10.1186/s40494018-0166-5
—María Dolores Gayo y Maite Jover de Celis, “Preparación de los lienzos: aparejos e imprimaciones en la pintura española del siglo XVII”, Ciencia y Arte VII (2021), pp 138-48.
63rd Dornbirn-GFC
11 al 13 de septiembre de 2024
Dornbirn (Austria) https://www.dornbirngfc.com/en/home
Thailand Lab International 11 al 13 de septiembre de 2024
Bangkok International Trade & Exhibition Centre Bangkok (Tailandia)
China International Chemical Technology & Equipment Fair
11 al 13 de septiembre de 2024
Shanghai New International Expo Center Shangai (China)
Inter Supply International Trade Fair for the production of Tabacco Goods
19 al 21 de septiembre de 2024 Messe Westfalenhallen Dortmund (Alemania)
CISAP 11. International Conference on Safety & Environment in Process & Power Industry
15 al 18 de septiembre de 2024 Nápoles (Italia)
https://www.aidic.it/cisap11/
Arab Lab Live
24 al 26 de septiembre de 2024
Dubai (Emiratos Árabes Unidos) https://www.arablab.com/
Spain Smart Water Summit
17 al 19 de septiembre de 2024
Hotel Meliá Avda. de América
Madrid (España)
https://www.iagua.es/spain-smartwater-summit-2024
Gastech
17 al 20 de septiembre de 2024
George R Brown Convention Center
Houston (Estados Unidos)
https://www.gastechevent.com/

EnerH2O (2ª edición)
25 al 26 de septiembre de 2024
Exponor – Feria Internacional de Oporto`
Oporto (Portugal) https://enerh2o.com/
PMH2: V Encuentro Sectorial del Hidrógeno
8 de octubre de 2024
Hotel Meliá Castilla
Madrid (España) https://pmh2.com/
Iberquimia
24 de octubre de 2024
Bilbao (España)
https://www.industriaquimica.es/eve ntos/iberquimia-bilbao-2024

Hydrogen World Expo
23 al 24 de octubre de 2024. Messe Hamburg Hamburgo (Alemania) https://www.hydrogenworldexpo.com/
Filtech 2024
12 al 14 de noviembre de 2024
Koeln Messe Colonia (Alemania)
Analytica China 2024
18 al 20 de noviembre de 2024
Shanghai New International Expo Center
Yakarta (Indonesia)
SOLIDS Antwerp 2024
20 al 21 de noviembre de 2024
Antwerp Expo - Bouwcentrum
Bruselas (Bélgica)
Iberquimia
14 de noviembre de 2024
Barcelona (España)

Solids Antwerp 2024
20 al 21 de noviembre de 2024
Antwerp Expo (Bouwcentrum) Amberes (Bélgica)
Iberquimia
28 de noviembre de 2024
Madrid (España)
Valve World 2024
3 al 5 de diciembre 2024
Düsseldorf (Alemania)
https://www.valveworldexpo.com/
Autozum Salzburg
22 al 25 de enero de 2025
Messezentrum
Salzburgo (Austria)
https://www.autozum.at/de

Smagua 2025
4 al 6 de marzo de 2025
Zaragoza
https://www.feriazaragoza.es/smagua

Agrupan a todos los titulados universitarios superiores dedicados a la ciencia y tecnología químicas.
Consulta más información en www.quimicosmadrid.org
Lagasca 27, 1.º E, 28001 Madrid


· Agencia de colocación.



el colectivo que profesionalmente mejor
· Conferencias y seminarios.
· Formación continua.
· Revista Enlace.
· Programa Químicos Emprendedores.
· Correo electrónico corporativo.
· Asesoría fiscal.
· Asesoría laboral.
· Elaboración de informes.
· Premios profesionales.
· Descuentos preferentes.
· Visados.
· Certificaciones.


· Domicilio social.
· Sala de reuniones.
· Sala de conferencias.
· Hermandad de Químicos (Grupo hna).
· Compulsado y certificados.
· Secciones técnicas.
· Ventajas fiscales.

· Te apoya y promociona.
· Apoyo y representación social.
· Representación en Anque y Consejo General.



· Acto anual de san Alberto.




· Premios, menciones especiales.

· Te facilita los contactos y medios requeridos.
· Respeta tu libertad profesional (*).

· Te ofrece servicios adecuados para el ejercicio profesional.
· Defiende tus derechos.

· Te ayuda a tu integración profesional.
· Cuota deducible en la declaración de la renta.

(*) Aunque la colegiación es una exigencia legal obligatoria para ejercer la profesión (Art. 3.2, de la Ley 2/1974, de 13 de febrero, de Colegios Profesionales) en todos los campos de actividad (enseñanza, industria, autónomos, etc.).

· Su confianza y solidaria responsabilidad.






· Potenciar las relaciones interprofesionales en todos los campos.
· Contribuir a la mejora de la percepción social de la Química.





